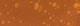

Vrijkaarten

première
APELDOORN - Vanaf zaterdag 24 tot en met vrijdag 30 december kan men aan De Voorwaarts genieten van het Wintercircus Apeldoorn. De première vindt plaats op zaterdag 24 december om 14.00 uur. Voor deze eerste voorstelling kan men gratis kaarten afhalen bij Nieuwsblad Stedendriehoek, Asselsestraat 140. Van zondag 25 tot en met donderdag 29 december zijn er twee shows per dag: om 13.00 en 16.15 uur. Op vrijdag 30 december ook twee, maar dan om 11.00 en 14.00 uur. Zie: www. wintercircusapeldoorn.com.

De beste wensen






LOENEN - Op een kerstkaart die je stuurt, of wanneer je elkaar weer ziet in het nieuwe jaar, is het goed gebruik om de beste wensen te doen. De kerstmusical in de Protestantse kerk, Beekbergerweg 7 in Loenen, heeft als titel ook ‘De beste wensen’. “Het toewensen is al mooi, maar om ook het goede te doen, om naar elkaar om te kijken, dat is waar het in deze kerstmusical maar ook in ons leven om draait”, aldus de organisatie. De musical wordt zaterdag 24 december om 19.00 uur opgevoerd.
Samen in Openheid



APELDOORN - Korak Herstelacademie in Apeldoorn en deelnemers van het Open Atelier stellen op woensdagmiddag 28 december hun gemaakte werk beschik baar voor een expositie. Het betreft schilder-, teken- en boetseerwerk, en dit alles onder de noemer Samen in Openheid. De opening vindt plaats om 13.00 uur bij Korak Herstelacademie, Jean Monnetpark 77.



Harrie Lavreysen in topvorm





De Brabander is olympischen wereldkampioen op de keirin en sprint en zal ook

op deze twee onderdelen uitkomen bij de nationale titelstrijd, die van dinsdag 27 tot







en met donderdag 29 december plaatsvindt in Omnisport Apeldoorn. Het is een druk



najaar voor Lavreysen. Eerst werd hij in Saint Quentin en Yvelines opnieuw wereldkampioen op de onderdelen sprint en keirin en veroverde hij zilver op de teamsprint. Vervolgens was hij een
van de absolute uitblinkers in de Champions League van de internationale wielerbond UCI en onlangs nog won hij de Sprint Cup in de Wooning Zesdaagse van Rotterdam. Lees verder op pagina 3.



Kerstverhaal komt tot leven Vrede, of… toch niet?



APELDOORN - Op vrijdag 23 december is er een orgel- en zangavond in de Eben-Haëzerkerk aan de Zonnedauw. Het belooft een
Methorst neemt de bezoekers mee door de rode draad van het programma. “We zingen samen en horen orgelliteratuur van onder anderen César Franck en Willem Mudde.”

Collecte

De toegang is gratis. Wel is er een collecte die volledig ten goede komt aan de voltooiing van het Steendamorgel in de Eben-Haëzerkerk.
APELDOORN - Op zaterdag 24 december brengen wijkgemeente De Hofstad, de Samuelkerk, M olukse G emeente GJPIN, G root Nieuws G emeente, het Leger des Heils en De Sleutel, het kerstverhaal tot leven in de wijk.











Wandeling Vanaf De Hofstad volgen deelnemers de ster die hen, al wandelend door de wijk,
meeneemt naar de verschillende momenten én hoofdrolspelers in het kerstverhaal. De deelnemers kunnen tussen 18.30 en 19.00 uur vertrekken vanaf het plein voor De Hofstad, Hofveld 52, nadat zij hier zijn ingeschreven net als in het echte kerstverhaal. Als kinderen een lampion hebben, mag die worden meegenomen. De wandeling eindigt met samenzang bij de stal in de

kerkzaal van De Hofstad.
Voor iedereen is daar warme chocolademelk en zijn er lekkernijen.
Samenzang
Voor degenen die niet in de gelegenheid zijn om mee te wandelen, is er om 19.00 uur een prachtig programma met veel samenzang van mooie, bekende kerstliederen in de kerkzaal van De Hofstad.
NIEUWSBLAD VOOR APELDOORN-DEVENTER-ZUTPHEN - OPLAGE CA. 154.340 EX. 47e JAARGANG NR. 51 - WOENSDAG 21 DECEMBER 2022 Onbetaalbaar... daarom gratis 68.700 huishoudens .nl
APELDOORN - Het Nederlands Kampioenschap Baanwielrennen is jaarlijks de plek waar het publiek de Nederlandse wielersterren en de talenten van de toekomst gezamenlijk in actie kan zien komen. Eén van de absolute sterren van het affiche is ook dit keer Harrie Lavreysen.
Ook voor andere kadootjes AROMA DIFFUSERS zuivering & -bevochtiging 2 jaar dan 25 AROMA DIFFUSERS Eyecatcher evt. met lichteffect Verdampt tot 8 uur lang Lucht zuivering & -bevochtiging Meer dan 25 soorten AROMA DIFFUSERS Eyecatcher evt. met lichteffect Verdampt tot 8 uur lang Lucht zuivering & -bevochtiging 2 jaar garantie Meer dan 25 soorten Koninginnelaan 97 | Apeldoorn | T. 055-5212662 Lees het gemeentenieuws op pagina 6 en 7 VERSTOPTE AFVOER OF RIOLERING? BEL Rioolreinigingsbedrijf B. Langenbach v.o.f. 055-5411660 of 06-55393920 www.langenbachvof.nl WINTERSALE 75% KORTING* TOTWEL Jutlandsestraat 3, Zutphen Tel: 0575-517999 - www.kachelswk.nl De wereld wordt rookvrij Wen er maar aan Ontdek hoe de wereld rookvrij wordt op rookvrij.nl
(Foto: Getty Images)
uit de gemeente Apeldoorn Nieuws
Feestdagen
Op donderdag 22 december is de laatste gemeenteraadsvergadering van dit jaar. Daarna begint de kerstvakantie. Op donderdagavond 12 januari 2023 zien we u graag weer tijdens de eerste Politieke Markt van 2023. De Apeldoornse gemeenteraad wenst u mooie kerstdagen en een goed en gezond 2023!

Ontmoetingen in 2022
Er waren het afgelopen jaar verschillende bijeenkomsten
de raadsleden en fractievertegenwoordigers kwamen luisteren naar wat de inwoners van Apeldoorn
houdt. Op de Dag van de Democratie in september kwamen veel Apeldoorners naar het Stadhuis om burgers & frietjes te eten én te praten met de raad. Ook de Ontmoetingsavonden in Uddel en Loenen werden drukbezocht en leverden de raadsleden veel nieuwe ideeën op. Dat smaakt naar meer... Dus ook in 2023 gaan we weer graag in gesprek met u! Houd onze nieuwspagina in deze krant én de website van de gemeenteraad (www.apeldoorn.nl/gemeenteraad) in de gaten!
Elke drie weken kunt u ‘In gesprek met de raad’ Agenda Gemeenteraad
Heeft u een onderwerp waar de gemeente beleid op zou moeten voeren, en dat u wilt bespreken met leden van de gemeenteraad? Dat kan elke drie weken op donderdagavond kunt u ‘In gesprek met de raad’.
‘In gesprek met de raad’ vindt plaats op donderdagavond (één keer per drie weken) van 19.00 tot 19.45 uur in het Stadhuis, Marktplein 1. Ook hoorzittingen maken deel uit van ‘In gesprek met de raad’. U kunt uw onderwerp voor ‘In gesprek met de raad’ direct aanmelden. U krijgt dan een ontvangstbevestiging. Daarna wordt uw onderwerp ingepland en krijgt u te horen wanneer, waar en hoe laat u welkom bent.
Het kan overigens voorkomen dat uw onderwerp niet in behandeling wordt genomen: dan wordt u daarover bericht. Dit gebeurt wanneer: uw onderwerp een individueel belang heeft; uw onderwerp onlangs in de Politieke Markt Apeldoorn aan de orde is geweest en afgehandeld; uw onderwerp verwikkeld is in een belemmerende gerechtelijke of gemeentelijke procedure, waardoor raadsleden niet vrijuit over het onderwerp kunnen spreken; uw onderwerp ‘onkies’, beledigend is en een commercieel belang heeft; uw onderwerp een aanvraag voor een subsidie of een toelichting daarop is; uw onderwerp een klacht is. Hiervoor bestaat een klachtenregeling.
donderdag 22 december
vanaf 19.00 uur
1. Opening 2. Vaststelling raadsagenda


3. Opvang van ontheemden Oekraïne en andere vluchtelingen
4. Afscheid raadslid J.D. van Zeist Besluiten raad:

5. Benoeming en installatie raadslid SP

6. Benoeming en installatie wethouder M. Wenzkowski
7. Benoeming en installatie raadslid Lokaal Apeldoorn
8. Benoeming fractievertegenwoordiger D66: dhr. P.A.W. Heijkamp 9. Rechtstreekse besluiten: a. Gewijzigde begroting 2023 Stedendriehoek b. Gewijzigde begroting 2023-2026 Tribuut
Apeldoorners kunnen op verschillende manieren meedenken met en invloed uitoefenen op de gemeenteraad.
Bijvoorbeeld kunt u tijdens Politieke Marktvergaderingen op donderdagavond meestal inspreken. U krijgt dan als inwoner van Apeldoorn aan het begin van de vergadering de gelegenheid om uw mening te geven over de kwestie waarover de gemeenteraadsleden vergaderen.
Meestal krijgt u ongeveer 5 minuten spreektijd als inspreker. Als er veel mensen willen spreken, geldt er een maximale spreektijd van 20 minuten voor iedereen samen, uitgaande van een vergadering van een uur. Eventueel kan de voorzitter beslissen de meesprekers het volle uur de tijd te geven en de
bijeenkomst op de volgende vergadering voort te zetten.
U kunt zich als inspreker aanmelden bij de Raadsgriffie. Dat kan per e-mail via otgriffie@apeldoorn.nl of telefonisch: 055-5801298.
U mag echter niet meepraten: als in de bijeenkomst een voorontwerp van een bestemmingsplan wordt behandeld; tijdens een ‘technisch blok’: een vergadering over niet-politieke, procedurele zaken; tijdens de mededelingen aan het begin van de bijeenkomst; tijdens de plenaire raadsvergadering.
Toehoorder
U kunt de vergaderingen van de gemeenteraad ook gewoon bijwonen als toehoorder. Dan is aanmelding vooraf niet nodig. U kunt de vergaderingen óók live online volgen.
Na de gemeenteraadsverkiezingen van 16 maart kreeg Apeldoorn een nieuwe gemeenteraad en een nieuwe wethoudersploeg. Veel
Apeldoorners kwamen kijken tijdens de installatie van de nieuwe raadsleden én de benoeming van de nieuwe wethouders.
c. Begrotingswijziging tijdelijke voetgangersbrug d. Vaststellen bestemmingsplan Frans van Mierisstraat 2 Apeldoorn e. Actualisering verordeningen en reglementen van de raad f. Vaststellen bestemmingsplan Greutelseweg 28 Wenum Wiesel g. Stopzetten communicatie
10. Verordening Maatschappelijke ondersteuning 2023 en verordening Zorg voor de jeugd 2023 11. Participatieverordening Apeldoorn dat zijn wij –inwonersparticipatie 12. Motie vreemd aan de orde van de dag ingediend door BVNL Apeldoorn: Geen laagvliegroutes boven de Veluwe



2
waarin
bezig
14.
22.00 uur Sluiting
in
Meer informatie: www.apeldoorn.nl/ gemeenteraad Een vergadering bijwonen of meedoen 2022: een nieuwe gemeenteraad
13. Vragenuurtje
Actualiteitsvragen
met drankje
Burgerzaal
Lavreysen dol op titels en truien

(vervolg voorpagina)






“Maar we gaan nog even door”, vertelde hij in Ahoy’. “Ik wil er ook op het Nederlands kampioenschap in Apeldoorn graag weer bij zijn. Ik heb me ingeschreven voor de sprint en de keirin, dat zijn mijn onderdelen. Aan de kilometer begin ik vooralsnog niet.” Lavreysen is dol op het veroveren van zoveel mogelijk titels en bijbehorende truien en vinkte vorig jaar nog de nationale sprinttitel af die nog ontbrak op zijn lijstje met gewonnen kampioenschappen. Maar hij is bovenal een geweldige ambassadeur van zijn sport. “Ik vind het Nederlands Kampioenschap vooral leuk omdat er ook jeugd meedoet. Ik ben overal in het buitenland tegen de besten van de wereld aan het fietsen. Maar ik wil

ook in Nederland laten zien wat ik kan en jeugd inspireren. Dat vind ik mooi en daar is het NK heel belangrijk voor. Ik ga ook feest vieren met de kerstdagen, maar wil ook voor de winst gaan
Winterse fietstocht


bij de kampioenschappen in Omnisport.”
Wie de sterren van de Olympische Spelen van Tokio en het WK Baan van Parijs eens van dichtbij in
actie wil zien en bekijken hoe zij de wedstrijden naar hun hand zetten op dé wielerpiste van Nederland, kunnen hun tickets aanschaffen via nkbaanwielrennen.nl. Daar vindt men ook het programma.

Herdertjestocht
Op vrijdagavond 23 december verzorgt de Goede Herderkerk, samen met de Grote Kerk, voor alle leeftijden de Herdertjestocht. Tussen 18.00 en 18.30 uur start men vanaf de Goede Herderkerk, Asselsestraat 199, als groepje met een tocht door de wijk.




Kerst met De Fontein

Geloofsgemeenschap De Fontein verzorgt op zaterdag 24 en zondag 25 december (eerste kerstdag) diverse kerstactiviteiten rondom wijkcentrum Het Kristal, Distelvlinderlaan 200 in Apeldoorn. Er is een kerstdiner voor ouderen, een wensboom en een kerstmusical. Ook wordt er chocolademelk uitgedeeld.














In de buurt van de supermarkt in Zuidbroek staat op zaterdag 24 december van 10.00 tot 16.00 uur een wensboom, waar mensen een kerstwens in kunnen hangen. Ook wordt er warme chocolademelk geschonken. Om 14.00 uur is er in de grote zaal een kerstmusical met als thema: ‘De moeite waard’. Deze musical is ingestudeerd door leerlingen van basisscholen in de wijk Zuidbroek en kinderen van De Fontein. Vanaf 17.00 uur zijn ouderen en mensen die wel een gezellige kerstavond kunnen gebruiken, welkom tijdens een diner, georganiseerd door jongeren van De Fontein. Om 20.00 uur is er een Xmas-singing op het plein of in de grote zaal van Het Kristal. Zondag 25 december is er om 10.00 uur een kerstviering in de grote zaal van Het Kristal. Voorganger is ds. Sjoerd Muller.
Vergunningen verleend Apeldoorn/Beekbergen
- Stationsplein (nabij nr. 6), plaatsen van 4 digitale reclamedragers op de perrons van treinstation - Engelanderweg 27, Beekbergen, kappen van een beuk (bijzondere boom)
- Paslaan 13, vervangen van enkelglas door isolatieglas






- Klingelbeek achter nr. 103, Ugchelen, kappen van een beuk - Laan van de Leeuw 4, kappen van 3 bomen - Bosweg 110, kappen van een lariks

- Burggraaf 32, Loenen, het plaatsen van een stacaravan
Vergunning geweigerd - Malkenschoten naast nr. 43, het kappen van 2 berken
- Hoogakkerlaan 4, kappen van een eik
Vergunningen aangevraagd Apeldoorn/Klarenbeek


- Asselsestraat 119, vergroten van woning en plaatsen van schuur - ‘t Hof 27, Uddel, plaatsen van een berging en een zwembad
- Rietdekkersdreef 401, plaatsen van een tuinhuis - Tweelingenlaan 10, verbouwen van een bedrijfspand en wijzigen gevel - Canadalaan 35, verduurzamen van een villa - Koninginnelaan 84A, vestigen van een tandtechnisch laboratorium - Ramsbrugweg 12 (begraafplaats), Wenum Wiesel, kap van 6 bomen - Krommedijk 5, Klarenbeek, wijzigen van het gebruik schuur naar b&b



Het Fietsgilde Apeldoorn houdt op woensdag 28 december de recreatieve Sylvestertocht. Deze dagtocht van ongeveer dertig kilometer vertrekt om 10.30 uur vanaf de parkeerplaats Dubbelbeek bij Aquacentrum Malkander, Dubbelbeek 56.
De route gaat over verharde wegen en fietspaden in
vlak en heuvelachtig terrein. De tocht is ook geschikt om met een driewielfiets te rijden. Fietsers kunnen tegen betaling van €2,50 deelnemen en eten en drinken zelf meebrengen. Deelnemers moeten zich van tevoren aanmelden, het liefst via e-mail: fietsgilde@ziggo. nl, maar telefonisch kan ook op werkdagen tussen 18.00
en 20.00 uur (06-83605380).












Vermeld bij aanmelding de datum van de fietstocht en het aantal personen. Er wordt gefietst in groepen, onder leiding van een gids die regelmatig stopt om allerhande bijzonderheden over de omgeving te vertellen.
Voor meer informatie: www. fietsgilde-apeldoorn.nl







Onderweg ervaart men scènes uit het kerstverhaal. De tocht voert naar een ontmoetingspunt met een warm welkom. Er zingt een koortje en er is voor iedereen warme chocolademelk. De wandeling duurt ongeveer een uur en eindigt weer bij de Goede Herderkerk. Na afloop is er buiten de kerk nog een versnapering voor alle wandelaars.

Bekendmakingen Gemeente 3 M P ...omdat de h inn ing blijft Bezoekadres: Koningslijn 3 | Apeldoorn | T. 055 - 5760585 info@hoogenberg-wegerif.nl | www.hoogenberg-wegerif.nl Openingstijden: ma. t/m vr. 9.00-17.00 u. en za. 9.00-14.00 u. MONUMENT MET VERSTEEND HOUT - meer dan 300 monumenten ter inspira�e in onze
modeltuin - alles naar wens ontworpen - naast natuursteen ook andere materialen zoals glas, RVS en cortenstaal
DECEMBER AANBIEDING € 19,95 OP = OP Kerstboeket op vaas asselsestraat 40 - 7311em - apeldoorn www.gorkink.nl - 055 3554585 - /eenbloemNL Wij wensen jullie jne feestdagen en een gezond 2023






























































GRATIS PARKEREN • ELADEN • FASHION CAFE • MODEMALL WILP WWW.PIETZOOMERS.COM KOM VOORDELIG SHOPPEN MET KORTINGEN TOT 50% OP AL ONZE TOPMERKEN! 2e KERSTDAG GEOPEND VAN 11 00 UUR TOT 17.00 UUR
Cliché cadeaus krijgen fraaie bestemming
ondergoed, doucheschuim en geurtjes? Alles is welkom!”











Snert van de Chef Orpheus steunt deze winter nog een lokaal goed doel door het verkopen van Snert van de Chef. Voor € 7,50 per liter geniet je thuis van deze heerlijke erwtensoep uit de keuken van Orpheus én help je minderbedeelde kinderen in de gemeente Apeldoorn. De helft van de opbrengst doneert Orpheus aan Stichting Leergeld Apeldoorn-Voorst. Zij bekostigt sociale activiteiten voor deze kinderen, zodat ze kunnen ‘meedoen’ met hun leeftijdgenootjes. Bestel de snert vóór 29 december via orpheus.nl/snert. Zolang de voorraad strekt.
Nog drie Sfeerdagen op De Roode Hoeve

Mirjam Barendregt, directeur van Orpheus, legt uit: “Ieder jaar komen weer die sokken, kaarsen en badschuim voorbij. Wij weten een origineler cadeau: theater! Theater
Orpheus biedt voor elk wat wils: cabaret, de mooiste concerten, prachtige toneelstukken, grootse musicals en
natuurlijk voorstellingen waar je met de (klein) kinderen of de hele familie van geniet.”
De cliché cadeaus die bij Orpheus worden ingeleverd, gaan naar de Apeldoornse Kledingbank Sant’Egidio. De plek waar mensen die financieel in de knel zitten, terecht kunnen voor meer dan alleen
kleding. Ronald Dashorst is blij met deze actie: “Op deze manier kunnen we een heleboel mensen letterlijk en figuurlijk warmte geven. Dus kom maar op met die cadeaus: voor de één cliché en onpersoonlijk, maar voor de ander een groot geschenk. Handschoenen, sokken,
“Lever op 6 januari 2023 tussen 16.00 en 18.00 uur je cliché cadeau(s) in bij Orpheus (Entree Zuid) en ontvang een € 5,- kortingsvoucher van Orpheus. De bestelde snert kan tevens op 6 januari tussen 16.00 en 18.00 uur opgehaald worden bij Entree Zuid van Orpheus. En onthoud voor op de verlanglijst: liever theater cadeau!”
Levend kerstverhaal in De Drie Ranken
APELDOORN - Wie op kerstavond, zaterdag 24 december, kerkgebouw De Drie Ranken bezoekt, wordt ondergedompeld in het kerstverhaal. Op die avond stap je terug in de tijd dat Jezus geboren werd.
Voor één keer is De Drie Ranken, Eglantierlaan 202 in wijk De Maten, omgebouwd tot een plaats waar soldaten
je oproepen om je in te schrijven, net als toen. Waar een profeet betere tijden aankondigt, net als toen. En waar
koningen, herders en engelen hun verhaal doen over het geheim van deze nacht. Net als toen.
Er zijn drie rondes: om 18.30, 19.30 of 20.30 uur. Het verhaal wordt afgewisseld met de oude vertrouwde
kerstliederen. Zo wordt het een feest voor alle leeftijden. Deze beleving duurt ongeveer 35 minuten. De start is bij de ingang aan de Eglantierlaan 202. Er staan potten om € 1,- bij te dragen, of meer. Zie ook de website www.3ranken.nl
middelpunt, tijdens deze sfeerdagen kan men juist genieten van gezelligheid en warmte binnenshuis.

In de grote Kapschuur vindt men tussen de hoge kerstbomen een stoere opstelling met tuin- en kerstbrocante, opgefleurd met groen/kerstdecoraties. Terwijl de Poort een winters witte uitstraling heeft gekregen, is de Deel dit jaar juist in een kleurrijke, oosterse kerstsfeer ingericht. In de sfeervolle Tuinkamer wordt koffie/thee geschonken en staat de cake met Nijbroekse vruchtencompote en slagroom klaar.


In de Achterzaal is opnieuw een prachtige collectie serviezen en (antiek) tafelgoed bijeengebracht. De fraai gedekte
tafels zijn een lust voor het oog. Kandelaars, flonkerend glaswerk, verzilverde bestekken - dit alles ter aanvulling of inspiratie van de eigen kersttafel.

De openingstijden zijn vrijdag 23, zaterdag 24 en maandag 26 december (tweede kerstdag) van 10.00 tot 17.00 uur. Eerste kerstdag gesloten. De entreeprijs is € 6,-, inclusief koffie/thee met gebak. De Roode Hoeve is gevestigd aan Middendijk 14 in Nijbroek. Voor meer informatie, telefoon 0571291670 en website www. tuinenderoodehoeve.nl.

- ADVERTORIALeen persoonlijke uitvaart voor elk budget Wouter Mondeel Apeldoorn U bent altijd welkom voor een open gesprek. Bel 055 - 357 44 72 of ga naar monuta.nl/ apeldoorn 5
NIJBROEK - Ook tijdens het kerstweekend zijn de Sfeerdagen op De Roode Hoeve in Nijbroek te bezoeken. Op deze monumentale IJsselhoeve worden traditiegetrouw in november en december bijzondere sfeerdagen georganiseerd. Staan in de zomer de prachtige tuinen in het
Vlijtseweg 232A Apeldoorn Tel. 055-3663064 b.g.g. 06-53659359 PRODUCT INFO IN DE SHOWROOM ALLEEN OP TELEFONISCHE AFSPRAAK Dé Dakraam specialist PRIJSVOORBEELD 55 x 78 € 755,00 Vraag naar de voorwaarden www.pws-dakramen.nl PWS BOUW S ERVICE Vrije golfer? Laat je registreren bij WHC De Scherpenbergh en profiteer van de voordelen! Een jaarlijkse contributie van € 115 en eenmalig inschrijfgeld van € 40 met deze faciliteiten: • NGF en handicap registratie, inclusief verzekering en golfjournaal. • Kortingen tot 30% op de greenfee prijzen van Golf- en Businessclub De Scherpenbergh. • Kosteloos gebruik van de oefenfaciliteiten van Golf- en Businessclub De Scherpenbergh. • Deelname aan leuke wedstrijden die maandelijks worden georganiseerd. • De mogelijkheid om deel te nemen aan het lesaanbod van Golfschool Apeldoorn. Beginnen met golfen was nog nooit zo eenvoudig! Complete beginners golfcursus voor € 195! • 12 uren golfles van een gediplomeerde golfprofessional. • Twee golfregelavonden inclusief NGF regelexamen. • Baanpermissie garantie bij aansluitend lidmaatschap van WHC De Scherpenbergh • Geen inschrijfgeld WHC De Scherpenbergh. • Onafhankelijk advies bij de aanschaf van een golfuitrusting. Voor vragen en aanmeldingen? Golf@scherpenbergh.nl, 055 5051262, www.whcdescherpenbergh.nl Golf-en Business Club De Scherpenbergh Albaweg 43, 7364 CB Lieren T. 055-5051262 WHC DE SCHERPENBERGH
APELDOORN - Sinterklaas is achter de rug en Kerstmis staat voor de deur. De tijd om elkaar cadeaus te geven. Maar, wat geef je dit jaar weer cadeau? Theater Orpheus heeft de oplossing: stop met de cliché geschenken en geef theater cadeau! Krijg je nu toch nog een cliché cadeau, dan mag je de kerstsokken, badschuim of dat boek dat je al hebt bij Orpheus inleveren op vrijdag 6 januari. Van Orpheus ontvang je dan een tegoedbon van € 5,- voor een voorstelling of concert naar keuze.
FIJNE FEESTDAGEN EN EEN GOED 2023
GEMEENTENIEUWS
COLOFON
Gemeente Apeldoorn www.apeldoorn.nl www.facebook.com/gemeenteapeldoorn www.twitter.com/gem_apeldoorn Marktplein 1, Postbus 9033 7300 ES Apeldoorn gemeente@apeldoorn.nl telefoon 14 055
VAN DE BURGEMEESTER
Aftellen
Weer zo’n jaar dat bijna voorbij is. Hoe was uw jaar?
Voor ons jaarlijkse kerstfilmpje stelde ik deze vraag aan een aantal voorbijgangers. En ook wat ze wensten voor het komende jaar.
Er kwam een dwarsdoorsnede van de gebeurtenissen van afgelopen jaar voorbij. Een nog jonge vrouw die nog steeds kampte met de gevolgen van long-covid. Een mevrouw die last had van de hoge energiekosten. Iemand die vijf jaar geleden het eigen land ontvlucht was. Een dame die haar tweede achterkleinkind hoopte te krijgen.
De wens die me het meest is bijgebleven is deze: dat alle mensen elkaar het komende jaar wat meer in hun waarde laten. De inwoonster die dat zei, vond dat het daar wel wat aan geschort had, het afgelopen jaar. En ik snap wat ze bedoelt. In het publieke debat ging het er geregeld hard aan toe.
Eén van die onderwerpen die tot felle meningsverschillen heeft geleid, is vuurwerk. Zoals u wellicht weet, is Apeldoorn één van de twaalf Nederlandse gemeenten waar alleen nog vuurwerkbedrijven (met vergunning) vuurwerk mogen afsteken. De 39 Apeldoornse burgers die samen de gekozen gemeenteraad vormen, hebben daar de afgelopen jaren geregeld met elkaar over gesproken. En uiteindelijk heeft de meerderheid dit besluit genomen. Niet over één nacht ijs, dus.
Ik weet dat sommige mensen knap chagrijnig zijn over dat besluit. De reacties op sociale media laten geen ruimte voor twijfel daarover. Maar er zijn ook veel mensen blij en opgelucht. Omdat oudjaar soms helemaal niet meer leek op een feest, maar op een crisis. Met doden, gewonden en heel veel schade. En dat is niet feestelijk meer.
In Apeldoorn gaan we er weer een super gezellig feest voor iedereen van maken. Met siervuurwerk voor de liefhebbers: er zijn maar liefst drie grote vuurwerkshows (twee op de Zwitsal en een in Uddel). Met een prachtige drone-lichtshow voor met name gezinnen met jonge kinderen (in het Zuiderpark). En met tientallen nieuwe, kleine en grote vuurwerkvrije feesten en activiteiten in wijken en buurten in de hele gemeente.
Ik snap dat het even wennen is, een jaarwisseling zonder zelf vuurwerk af te steken. Maar ik hoop dat we er over een aantal jaren met ons allen vooral blij om zijn.
Ik wens u alvast een feestelijke en bere-gezellige jaarwisseling!
Wij hopen dat 2022 een goed jaar voor u was, met veel mooie momenten. We hopen vooral ook dat 2023 een goed jaar voor u wordt. In goede gezondheid en met fijne mensen om u heen. Dat gunnen we iedereen. Onze inwoners en ondernemers. Onze jongeren en onze ouderen. Onze verenigingen, onze leraren, politiemensen,
APELDOORN TELT AF!
In Apeldoorn vieren we oud en nieuw vanaf dit jaar zónder consumentenvuurwerk (behalve F1), maar wél met elkaar. We sluiten het jaar namelijk kleurrijk af met drie grote aftelfeesten: in het Zuiderpark, het Zwitsalterrein en bij het Dorpshuis in Uddel.
In het Zuiderpark geniet u om 18.30 sámen met het gezin van een spektakel van drones, laserstralen en geluid: een show helemaal van nu! De show is leuk voor jong en oud, maar voor-
werkers in de gezondheidszorg. Onze vrijwilligers. En de mensen die het afgelopen jaar bij ons hun toevlucht hebben gezocht omdat het in hun land nu niet veilig is.
In Apeldoorn is het goed, prettig en veilig wonen. Dat vraagt wel om blijvende aandacht en inzet. We beloven
u dat we ons daar ook in 2023 met hart en ziel aan zullen wijden. In goede samenwerking en in nauw contact met u.
We wensen u fijne feestdagen en een gezond en gelukkig 2023.
Het college van burgemeester en wethouders gemeente Apeldoorn
Telefonisch bereikbaar van maandag tot en met vrijdag van 8.00 tot 17.00 uur
Publieksbalie
U kunt uitsluitend op afspraak terecht. Wmo-loket voor wonen, welzijn en zorg www.apeldoorn.nl/wmo-loket telefoon 14 055
Telefonisch bereikbaar van maandag tot en met vrijdag van 8.30 tot 16.00 uur
Heeft u de Stedendriehoek niet ontvangen, neem dan contact op met 055-303 49 01.
FEESTDAGEN VAN NIX
Kerst en Oud & Nieuw komen eraan. Veel volwassenen drinken dan alcohol. Ook kinderen krijgen tijdens de feestdagen soms de kans om een glaasje te drinken of te ‘proeven’. Vooral voor kinderen die nog in de groei zijn is het schadelijk om alcohol te drinken. Tips om hier als ouder mee om te gaan tijdens de feestdagen vindt u op de website www.helderopvoeden.nl.

al voor kinderen tot ongeveer 14 jaar. Vanaf 17.00 uur maakt de DJ er al een mooi feest van, zodat iedereen zichzelf al dansend warm kan houden én de eerste 500 bezoekers krijgen een gratis oliebol.
Op het Zwitsalterrein kunt u van 20.30 tot 01.00 uur vertoeven. In de overdekte Zwitsalhal geniet u van een hapje en drankje onder muzikale begeleiding van een DJ die de leukste plaatjes voor u draait. Om 21.30 en 23.55 zijn er twee grote vuurwerk-
shows. Zéker tijdens de laatste show telt iedereen met elkaar af naar 2023. Een geweldig feest dat u niet mag missen. Ook hier krijgen de eerste 500 bezoekers een gratis oliebol. Ook in Uddel wordt het gezellig bij het Dorpshuis. Daar kan iedereen van 21.30 tot 23.30 genieten van een drankje, gezelligheid én om 22.30 uur ook van een grote vuurwerkshow.
Meer informatie over de aftelfeesten vindt u op de website www.vuurwerkvrijapeldoorn.nl.
PETER-JAN DE WILDE WORDT NIEUWE STADSDICHTER


Peter-Jan de Wilde wordt de nieuwe Stadsdichter van Apeldoorn. Hij neemt in januari de pen over van de Stadsdichter Herman Kattemölle.
Peter-Jan zal de aankomende twee jaar deze rol vervullen.
De stadsdichter is ‘poëtisch ambassadeur’ van Apeldoorn. Iemand die met een speciale blik naar de stad kijkt, ziet wat anderen niet zien en zegt wat anderen niet zeggen. Actuele Apeldoornse gebeurtenissen, maatschappelijke thema’s en alledaagse dingen vormen de inspiratie voor de gedichten. Een
deel van deze gedichten wordt uitgebracht op ansichtkaarten, die gratis te krijgen zijn bij verschillende boekhandels in Apeldoorn. Ook draagt de Stadsdichter zijn gedichten voor bij speciale gelegenheden.
Op donderdag 26 januari, tijdens de Nationale Poëzieweek in CODA, wordt de nieuwe Stadsdichter voorgesteld aan het Apeldoornse publiek. Dit is ook het moment waarop we afscheid nemen van onze huidige Stadsdichter Herman kattemölle. Kijk voor meer informatie op de website www.apeldoorn.nl/stadsdichter.
VRIJWILLIGERS DE ZONNEBLOEM AFDELING APELDOORN WEST GEHULDIGD
Woensdag 14 december werden Tonnie Jansen en Coba van Essen gehuldigd door wethouder Danny Huizer. Tonnie en Coba zijn beiden al dertig jaar vrijwilliger bij de Zonnebloem in verschillende functies. Met een enthousiaste groep
van 63 vrijwilligers zetten ze zich op afdeling Apeldoorn West in voor mensen met een lichamelijke beperking vanaf 18 jaar. Beiden ontvingen een waarderingsbeeldje en bloemen als dank namens de gemeente.
VOLG DE GEMEENTE
VIA SOCIAL MEDIA
• Facebook: gemeenteapeldoorn


• Twitter: gem_apeldoorn

• Instagram: gemeenteapeldoorn
• LinkedIn: Gemeente Apeldoorn

Wilt u een persoonlijk gesprek met een professional over het alcoholgebruik van uw kind, van uzelf of van een naaste? Dan kunt u contact opnemen met een medewerker van Tactus via het mailadres e.meijer@tactus.nl (Evelien Meijer) of jeroen.jansen@tactus.nl (Jeroen Jansen) van Tactus.
Dry January
Wilt u als ouder het goede voorbeeld geven en geen of minder alcohol drinken? Doe dan mee aan Dry January. Inschrijven kan op de website www.ikpas.nl.
AZC DEVENTERSTRAAT OFFICIEEL GEOPEND
Het nieuwe AZC aan de Deventerstraat is dinsdag 13 december officieel geopend.
De bestaande gebouwen op het terrein zijn helemaal gerenoveerd en klaar voor bewoning. In november zijn 300 bewoners naar deze nieuwe locatie verhuisd. Deze 300 mensen woonden hiervoor in de tijdelijke opvang aan de Christiaan Geurtsweg. De burgemeester hoopt dat er een goede wisselwerking ontstaat tussen de bewoners en de directe omgeving. Om dat te bevorderen is er een beheergroep, ook met omwonenden, om ervaringen uit te wisselen en te kijken of alles goed gaat.
21 DECEMBER 2022
Foto: Gemeente Apeldoorn
Ton Heerts
Foto: Peter Lous
NK BAANWIELRENNEN
IN APELDOORN
Van dinsdag 27 tot en met donderdag 29 december wordt het Nederlands Kampioenschap Baanwielrennen gehouden in Omnisport. Het Kampioenschap duurt drie dagen met een mooie afwisseling van sprint- en pelotonsonderdelen. Zowel mannen, vrouwen, jeugd en Paracycling strijden om de titel. Wilt u hierbij zijn? Kijk voor meer informatie of voor tickets op de website www.nkbaanwielrennen.nl.
AUDIOTOUR OVER
APELDOORNSE
BUITENKUNST
Apeldoorn heeft veel kunst in de openbare ruimte. Voor inwoners en bezoekers die daar meer over willen weten is er een gloednieuwe audiotour ‘Natuurlijk Buitenkunst’. In een fietsroute van 18 kilometer zijn de verhalen over 14 buitenkunstwerken te horen. De audiotour is te downloaden via de Apeldoorn Stories app.
De route start en eindigt naast het ACEC gebouw aan de Roggestraat. Vanaf dat punt beginnen ook de audiotours ‘Stadsnatuur’ en ‘Rondje Cultuurkwartier’. Op het nieuwe informatiebord naast de ingang van de fietsenstalling staat een handig overzicht van de routes die hier starten.

Over Apeldoorn Stories
In de Apeldoorn Stories app zijn audiotours over Apeldoorn gebundeld. De meeste starten in of rondom de binnenstad. Van fiets- tot wandelroutes en voor jong en oud. Meer informatie is te vinden op de website www.apeldoornstories.nl.
BINNENSTAD IN TEKEN VAN WINTERSFEREN

De komende dagen kunnen bezoekers van de binnenstad genieten van ‘Wintersferen’. Van dinsdag 20 tot en met vrijdag 23 december kunt u een aantal sfeervolle activiteiten verwachten.



Op zes gebouwen in het centrum worden bijzondere videobeelden geprojecteerd. Het hoogtepunt is op donderdag 22 december vanaf 20.30 uur op het Marktplein. Dan komt de rijke, koninklijke geschiedenis namelijk tot leven via een grote videoshow op het stadhuis op het Marktplein: het Wintersferen Videospektakel. Tijdens deze show worden videoprojecties gecombineerd met livemuziek en andere verrassende optredens. Een magisch moment dat u niet wil missen.
Meer informatie vindt u op de website www.uitinapeldoorn.nl/wintersferen.

ACTIVITEITEN
Op de website www.overheid.nl/ berichten-over-uw-buurt vindt u berichten over actualiteiten, zoals vergunningen, in uw buurt. Om op de hoogte te blijven van deze activiteiten kunt u zich aanmelden voor een email-service. Als er een bericht is geplaatst die aan uw voorkeuren voldoet, dan ontvangt u een mail. Zo mist u niets van de laatste ontwikkelingen in uw buurt.
NIEUW ONTWERP SPOORFIETSPAD
NATURALISATIEDAG
Tijdens de landelijke Naturalisatiedag op 15 december werd er een feestelijke bijeenkomst in Werkgebouw Zuid gehouden. Hier werd gevierd dat 95 mensen dit jaar de Nederlandse nationaliteit kregen. Dit werd samen met samen met de partners, kinderen en kennissen gevierd. Wethouder Sunita Biharie mocht als loco-burgemeester de bijeenkomst begeleiden. “Al deze mensen hebben hier hard voor gewerkt, bijvoorbeeld door de Nederlandse taal te leren. Ik vond het een grote eer om hen te mogen feliciteren met het feit dat ze Nederlander geworden zijn.”
Het nieuwe spoorfietspad gaat van 2 naar 3,5 meter breedte. Met deze verbreding voldoet het fietspad aan de huidige normen van tweerichting fietspaden. Daarnaast worden alle kruisingen met zijwegen overzich-
telijker gemaakt en krijgt de fietser bijna overal voorrang. Bij de beekkruisingen worden nieuwe, bredere brugdekken aangebracht en de cultuurhistorische landhoofden blijven daarbij behouden. Omdat het fietspad
TIENTALLEN GROEPEN EN BUURTEN AAN DE SLAG MET VUURWERKVRIJ OUD & NIEUW
De gemeenteraad stelde 75.000 euro beschikbaar voor mooie initiatieven tijdens de jaarwisseling. Dit bedrag is bedoeld om samen met de buurt, vereniging of anderen het nieuwe jaar vuurwerkvrij in te luiden. Tot 1 december kon er een aanvraag ingediend worden. In totaal zijn er 52 aanvragen ingediend waarvan er 49 zijn toegekend. In totaal gaat het om een bedrag van 70.590 euro.
Van samen oliebollen bakken tot lasergamen en van muziek maken met de buurt tot een lasershow: vanuit de hele gemeente kwam er een grote variatie aan aanvragen binnen. En het mooie is: bij alle activiteiten staat samenzijn en verbinding centraal .






Wethouder Anja Prins van inwonersparticipatie: “Wij zijn ontzettend blij met dit mooie resultaat en alle gave initiatieven die zijn ingediend vanuit onze stad en dorpen! Dit bewijst voor mij weer dat we samen echt sterker zijn en meer bereiken. Samen maken we Apeldoorn een mooie en fijne plek om te wonen. Een plek waar we er ook zijn voor elkaar. Ik wens, ook namens het college, iedereen in Apeldoorn een feestelijke, gezellige en veilige jaarwisseling toe.”

Apeldoorn telt af!
Tijdens de jaarwisseling geldt er in Apeldoorn een afsteekverbod voor consumentenvuurwerk. Om samen het nieuwe jaar feestelijk in te gaan, worden er drie grote aftelfeesten georganiseerd: in het Zuiderpark, op het Zwitsalterrein en bij het Dorpshuis in Uddel. Op vuurwerkvrijapeldoorn.nl leest u hier meer over.
Regels rondom vuurwerk
In juli 2021 heeft de gemeente in de Algemene Plaatselijke Verordening (APV) opgenomen dat het afsteken van consumentenvuurwerk tijdens de jaarwisseling in de gemeente Apeldoorn is verboden. Iedereen vanaf 12 jaar mag wel fop- en schertsvuurwerk afsteken, zoals sterretjes, grondbloemen, Bengaals vuur, knalerwten, trekrotjes.
Als u tijdens de jaarwisseling professioneel vuurwerk wilt laten afsteken via een bedrijf, zoals een vuurwerkshow, dan moet dat bedrijf daarvoor een vergunning aanvragen. Naast deze Oud & Nieuw regeling, ondersteunt de gemeente het hele jaar door inwoners die mooie ideeën hebben voor hun buurt of wijk. Voor meer informatie kijk op de website www.apeldoorn.nl/ inwonersinitiatieven.
GEWIJZIGDE OPENINGSTIJDEN STADHUIS
Op Tweede Kerstdag (26 december) is het stadhuis gesloten. Een aantal zaken regelt u makkelijk en snel via de website www.apeldoorn.nl. Dinsdag 27 december kunt u het stadhuis weer bezoeken of bereiken via telefoonnummer 14 055.
in dit nieuwe plan uiteindelijk minder breed wordt dan bij de snelle fietsroute, kunnen veel bosschages behouden blijven en worden er minder dan tien bomen gekapt.
De volgende stap is dat de gemeenteraad zich over dit nieuwe ontwerp buigt. Als alles meezit, kunnen we eind 2023 over het nieuwe, comfortabele en veilige fietspad fietsen.
Lees het volledige nieuwsbericht op de website www.apeldoorn.nl.
GEEN AFVAL INZAMELING OP 2E KERSTDAG
Op Tweede Kerstdag (26 december) zamelt Circulus geen huishoudelijk afval in. Kijk voor de vervangende inzameldagen in de Circulus-app of op de digitale afvalkalender op de website www.circulus.nl.





IN UW BUURT vuurwerkvrijapeldoorn.nl Zuiderpark Droneshow 17.00 -19.00 uur Zwitsalterrein Vuurwerkshows 20.30 - 01.00 uur Dorpshuis Uddel Vuurwerkshow 21.30 - 23.30 uur Apeldoorn telt af! Kom naar de aftelfeesten en vier de jaarwisseling samen!
De gemeente Apeldoorn wil de fietsroute over het voormalige spoor tussen Apeldoorn en Vaassen, de zogenaamde Baronnenroute, verbeteren en veiliger maken. Eerder was het de bedoeling om hier een hoogwaardige snelfietsroute te realiseren, maar met name de hoge kosten en de grote impact op het landschap hebben de plannen gewijzigd. Dat laatste was ook een groot zorgpunt van veel omwonenden. Het college van B&W heeft nu ingestemd met een nieuw plan dat de fietsroute comfortabeler en veiliger maakt.
Foto: Gemeente Apeldoorn
Foto: Gemeente Apeldoorn
Winterweer
Ook in deze wintermaanden doen wij ons uiterste best de inzameling goed te laten verlopen. Maar bij gladheid of sneeuw kan onze dienstverlening hinder ondervinden. Houd bij streng winterweer onze app en website www.circulus.nl in de gaten voor het laatste nieuws.
Voorkom vastvriezen
Bij (nacht)vorst kan het voorkomen dat de inhoud van uw container vastvriest. De inzamelwagen schudt de container stevig heen en weer, maar soms komt de inhoud dan niet of niet helemaal los. Een vervelend ongemak. Tips: Als het kan, zet uw container dan thuis tijdelijk op een beschutte plek. Laat nat groente- en fruitafval zoveel mogelijk uitlekken voor u het in de groene container doet. U kunt bij gft ook speciale composteerbare gft-inzamelzakken gebruiken.
Inzameling kerstbomen
Gezellig: een kerstboom in huis. Wilt u de boom in januari weer kwijt? Maak dan gebruik van de gratis inzameling!
Circulus haalt van 9 tot en met 20 januari bij alle inwoners van de gemeente Apeldoorn de fijnsparren, Nordmann-sparren en andere echte kerstbomen op. Weten wanneer we in uw wijk of dorp langskomen? Dat ziet u in de app en digitale kalender van Circulus. U herkent uw inzameldag aan het kerstboompje. Vooraf aanmelden is niet nodig.
Leg uw kerstboom op de inzameldag zonder pot en versiering voor 7.30 uur aan de weg. Doe dit op de plek waar u normaal de container zet of in de buurt van de ondergrondse restafvalcontainer.
Van 2 tot en met 14 januari kunt u uw kerstboom ook gratis wegbrengen naar het Recycleplein in Apeldoorn. U kunt terecht op het inleverplein voor gratis afvalsoorten, ingang Aruba 12. Openingstijden: van maandag tot en met zaterdag van 7.45 tot 16.30 uur. Let op: er is geen speciale avondopenstelling voor het wegbrengen van kerstbomen!
Tip: Doe de lege pot van de kerstboom bij het restafval of lever gratis in als hard kunststof op het Recycleplein. De potten horen niet bij pmd: ze geven vanwege het formaat problemen bij de verwerking van pmd.
Plet je pakketje
Brengt u dozen weg naar de ondergrondse papiercontainer? Maak deze dan goed plat door te stampen, scheuren of knippen. Hoe kleiner en netter het karton de container in gaat, hoe meer erin past en hoe netter de buurt blijft. U kunt dozen ook gratis wegbrengen naar de papiercontainer op het Recycleplein. Zorg ervoor dat uw papier en karton droog is, dat kunnen we het goed recyclen.

Lever lege batterijen in!

Een kerstkaart die muziek maakt, speelgoed en kerstversiering… in veel producten zitten batterijen. Haal de lege batterijen er altijd uit en lever ze apart in. Dat kan gratis bij supermarkten, bouwmarkten, de chemokar en bij het Recycleplein. Lege batterijen bevatten waardevolle metalen, zoals ijzer, lood, zink, mangaan, kobalt en nikkel die hergebruikt worden. Dank u wel!
Geen inzameling op feestdagen
Op 26 december (2e kerstdag) zamelt Circulus geen huishoudelijk afval in. Kijk voor de vervangende inzameldagen in de Circulus-app of de digitale afvalkalender op www.circulus.nl. Plaats ook op de inhaaldagen uw container vóór 7.30 uur aan de weg.
Gewijzigde opening Het Recycleplein aan de Aruba is op 26 december (2e kerstdag) gesloten. Op 24 en 31 december gaan we eerder dicht: het Recycleplein sluit dan om 15.30 uur.
Drukte op Recycleplein Tussen kerst en oud en nieuw is het naar verwachting extra druk op het Recycleplein aan de Aruba. Houd rekening met langere wachttijden of probeer uw bezoek op een ander moment te plannen.
Frituurvet- en olie recyclen Gaat u oliebollen bakken en heeft u straks frituurolie of -vet over? Giet de afgekoelde olie of het vet dan in een plastic fles, bijvoorbeeld de originele verpakking. Lever het gratis in op het Recycleplein, er wordt biobrandstof van gemaakt! Meer informatie: www.frituurvetrecyclehet.nl
De bak aan de weg in 2023
Check ‘t in de app van Circulus!












Hoe makkelijk is dat: een seintje als de bak aan de weg moet. In de Circulus-app vindt u de inzameldagen van 2023 en krijgt u een berichtje van ons wanneer we langskomen.
U vindt de app in de App store en Google Play.
Wij wensen u fijne feestdagen! Meer informatie Heeft u een vraag aan Circulus? Kijk dan op www.circulus.nl of neem contact op met ons KlantContactCentrum. We helpen u graag verder. WhatsApp: 06 - 10 50 73 00, contactformulier op www.circulus.nl Telefoon: 0900 - 9552 (geen toeslag) Ganaardeapp ..de Circulusnieuwe app!
Techniek en creativiteit bij TechnoDiscovery
“Tijdens deze sessies werd regelmatig gevraagd of kinderen ook op andere momenten bij TechnoDiscovery aan de slag kunnen. Tot nog toe niet, maar we willen zeker onderzoeken of dit tot de mogelijkheden behoort. Daarom gaat Creawijz deze kerstvakantie vier sessies aanbieden waarin kind en ouder
samen creatief aan de slag kunnen. Tijdens de kerstvakantie kunnen kinderen van 7 tot 13 jaar met één ouder aan de slag bij TechnoDiscovery Apeldoorn, Vlijtseweg 148 (NewTechPark). Techniek en creativiteit toepassen tijdens een sessie van twee uur. Zie voor meer informatie de website: creawijz.nl/

techniek-en-creativiteit-bijtechnodiscovery
De sessies zijn op vrijdag 30 december van 10.00 tot 12.00 uur en van 14.00 tot 16.00 uur, en op vrijdag 6 januari van 10.00 tot 12.00 uur en van 14.00 tot 16.00 uur. “Wij zorgen ervoor dat de hamers, spijkers, boor- en schroefmachines,
Nostalgische kerstdienst
APELDOORN - Gereformeerde Kerk De Voorhof, Gijsbrechtgaarde 101, houdt op zaterdag 24 december een kerstnachtdienst.

Tijdens deze nostalgische kerstdienst worden bekende kerstliederen gezongen en is er een mooie overdenking over de impact van kerst. Dominee Marinus Beute vertelt over het kerstverhaal uit het Bijbelboek Lucas. Daar
zegt de engel tegen de herders: ‘Jullie hoeven niet bang te zijn, er is goed nieuws dat zal leiden tot grote vreugde!’
Inloop “Wat gebeurt met kerst heeft impact. Dat betekent iets voor de wereld. Maar vaak staan we daar niet genoeg bij stil. We hebben er met elkaar een feest vol onnodige stress van gemaakt. Dit jaar geen kerststress, maar

kerstvreugde. Maak het ook mee en wees welkom in de kerk met kerst.” De inloop is vanaf 21.00 uur. Er is dan wat lekkers te drinken en buiten staan vuurkorven. De dienst start om 21.30 uur.
Zondag 25 december is er om 10.00 uur ook een feestelijke kerkdienst in De Voorhof. Zie ook de website: www. kerkdevoorhof.nl/actueel/ actueel/kerstnachtdienst.
schroeven, zagen en lijmpistool klaar staan. Er zijn nog apparaten die gedemonteerd kunnen worden en daar kun je natuurlijk een leuk blokbotje van maken. Gereedschap hiervoor is aanwezig. Daarnaast kun je ook met houtbranden aan de slag. We zijn vanuit Creawijz met twee mensen aanwezig, dus als je vragen hebt of even niet weet hoe iets werkt, dan helpen we je. Let wel even op dat je samen met een volwassene komt die het ook leuk vindt om samen met jou creatief bezig te zijn en koop op tijd een ticket. Er is voor zowel jong als oud iets leuks te maken, wat je na afloop natuurlijk mee naar huis neemt.”
Tickets kosten € 8,50 per kind en zijn te bestellen via shop. eventix.io/f8e98249-6f1811ed-aa54-6a57c78572ab/ tickets. De sessies gaan door bij een minimale aanmelding van tien kinderen. Mail voor meer informatie naar creawijz@gmail.com.






Dinsdag 20 tot en met vrijdag 23 december



WINTERSFEREN IN DE BINNENSTAD
Artistieke videoprojecties op zes panden, koninklijke historie gebundeld in een audiotour en als kers op de taart een grootse videoshow op het stadhuis. Onder de noemer ‘Wintersferen’ kun je deze week genieten van sfeervolle activiteiten. Tijdens een wandeling langs markante panden in het centrum vergaap je je aan beelden die op de puien geprojecteerd worden. Het hoogtepunt is op donderdag 22 december vanaf 20.30 uur op het Marktplein. Dan komt de rijke, koninklijke geschiedenis namelijk tot leven middels een grote videoshow op het stadhuis. Tijdens deze show worden videoprojecties gecombineerd met livemuziek en andere verrassende optredens. uitinapeldoorn.nl/wintersferen

Donderdag 22 tot en met maandag 26 december KERSTBORRELS HORECA

De horeca trakteert je op diverse borrels en liveoptredens voor kerst én tijdens kerst. We hebben alle tips voor je verzameld! uitinapeldoorn.nl/ kerstborrels
Vrijdag 23 december tot en met zaterdag 7 januari KERSTVAKANTIETIPS


Eropuit deze kerstvakantie? We hebben talloze uitjes op een rij gezet. Van attractie tot wandeling en van circus tot koninklijk genieten! uitinapeldoorn.nl/ kerstvakantie

Voor een actueel overzicht van alle activiteiten: uitinapeldoorn.nl
Snel leverbaar, dus maak nu een proefrit.

Gecombineerd verbruik: 1,38 - 6,6 (l/100 km) / 15,2 - 72,5 (km/l); CO2 - emissie: 31 - 152 (gr/km). Uitstoot- en brandstofverbruiksgegevens zijn gebaseerd op tests die zijn uitgevoerd volgens de Europese richtlijnen EU 2018/1832 en 2017/1151. De vermelde WLTP-waarden voor het gecombineerde brandstofverbruik en de CO2-uitstoot zijn overeenkomstig de nieuwe WLTP-testmethodiek. De waarden zijn afhankelijk van de gekozen uitvoering en wielmaat. De actieradius kan in de praktijk o.a. variëren door omstandigheden op de weg, rijstijl en temperatuur. De Hyundai ‘5 jaar garantie zonder kilometerbeperking’ en de ‘8 jaar of 160.000 kilometer batterijgarantie’ zijn alleen van toepassing op Hyundai voertuigen die initieel aan een eindgebruiker zijn verkocht door een erkend Hyundai-dealer. De Hyundai Smart bonus actie bestaat uit een maximaal voordeel tot € 500 op het aankoopbedrag van een Hyundai TUCSON. Actie geldt bij een getekende koopovereenkomst tot en met 31-12-2022 met een uiterste registratiedatum van één maand na koopovereenkomst. Actie is van toepassing op particuliere transacties. Acties zijn niet geldig in combinatie met andere lopende acties. Hyundai Operational Lease prijs is een prijs incl. BTW, o.b.v. 60 maanden looptijd en 10.000 km per jaar en geldt voor een Hyundai TUCSON 1.6 T-GDI 48V MHEV i-Motion. Hyundai Operational Lease wordt aangeboden in samenwerking met Arval. Arval is voorzien van het Lease Keurmerk. Genoemde prijs is een adviesprijs en is excl. metallic lak en eventuele opties. Genoemde bedragen zijn onder voorbehoud van prijswijzigingen en verschillen per model. Kijk voor prijzen en voorwaarden op hyundai.nl of vraag ernaar bij de erkende Hyundai-dealer. De gedetailleerde garantievoorwaarden zijn beschreven in het service- & garantieboekje. Afgebeeld model en kleur kunnen afwijken van standaarduitvoering en beschikbare productiekleur. Druk- en zetfouten voorbehouden. Onbeperkte Kilometer Garantie Batterij Garantie 8 Ontdek meer op hyundai.com/nl/herwers Apeldoorn: Laan van de Dierenriem 29, tel. 055 - 369 6212 Arnhem: Hazenkamp 15, tel. 026 - 362 80 80 Deventer: Solingenstraat 3, tel. 0570 - 519 360 Doetinchem: Plakhorstweg 14, tel. 0314 - 333 055 Tiel: Stephensonstraat 21, tel. 0344 - 630 500 Veenendaal: Galileistraat 12, tel. 0318 - 529 555 Trekauto van het Jaar – ANWB (NL) , Beste familieauto – Carbuyer Best Car Awards (GB), Best geteste Plug-In Hybrid SUV – Autobild (DE). Van talloze bekroningen naar Europa’s bestverkochte SUV in zijn segment. De TUCSON is een geavanceerde én opvallende
keus. De Hyundai TUCSON. Europa’s bestverkochte SUV in zijn segment. € 518 p.m. Operational Lease vanaf Obv 60 mnd / 10.000 km/p.j. (incl. € 500 Smart bonus) € 36.995 Hyundai TUCSON vanaf
verschijning die voorzien is van vooruitstrevende connectiviteit en de beste veiligheidssystemen in zijn klasse. Deze krachtpatser is verkrijgbaar als Mild Hybrid, Hybrid en Plug-in Hybrid. Ervaar de TUCSON zelf en maak een proefrit in de TUCSON van je
9
Uittips
week
deze
APELDOORN - “De afgelopen weken hebben wij bij TechnoDiscovery het thema recycling verzorgd. Ongeveer zevenhonderd kinderen uit groep 5 tot en met 8 van het basisonderwijs hebben van restmateriaal nieuwe dingen gemaakt. Soms een gebruiksvoorwerp en een andere keer een waar kunstwerk”, vertelt Patricia van der Nat.
Burgemeesters stappen boordevol ideeën het
















Het jaar
WAT HEEFT HET JAAR 2022
 GEBRACHT VOOR UW GEMEENTE?
GEBRACHT VOOR UW GEMEENTE?
















TH: “Gelukkig weer eens een jaar dat niet helemaal in het teken stond van corona. Daar waren we ook wel weer aan toe. Wat natuurlijk wel een grote rol heeft gespeeld is de opvang van vluchtelingen, uit Oekraïne en uit andere landen. Met ons allengemeente, organisaties, inwoners en ondernemers - hebben we hard gewerkt om de vluchtelingen die naar Apeldoorn kwamen op te vangen en te helpen. En dat blijven we doen, zolang het nodig is. En iets leuks: op de valreep werd bekend dat Apeldoorn in Nederland de op twee-na-gezondste stad is. Namelijk een stad met veel groen, goed ingerichte buitenruimte en voorzieningen om elkaar te ontmoeten, veilig te spelen
enzovoorts. Dat is superbelangrijk, en dat doen we dus goed!”









RK: “Het jaar heeft Deventer veel gebracht. Maar hier wil ik stil staan bij één begrip: ‘thuis komen’. Veel internationale ontwikkelingen hadden hun effect, ook in onze regio. De oorlog in Oekraïne joeg veel mensen hun land uit. Ook in Deventer werd de noodopvang georganiseerd. Mede dankzij de inzet van vrijwilligers werden er zo’n 450 Oekraïense vluchtelingen opgevangen in voormalige bedrijfspanden aan de Keulenstraat en aan de Singel en boven het vroegere Filmhuis in de Keizerstraat konden 78 vluchtelingen terecht. Het was hartverwarmend om te zien dat tientallen Deventenaren een logeeradres aanboden aan Oekraïners, gewoon bij hen thuis. Later dit jaar omarmde de stad de ruim 170 vluchtelingen die wij een tijdelijk onderkomen bieden op een schip aan het Pothoofd, vlakbij de Wilhelminabrug.”
AV: “Het is een veelbewogen jaar geweest. De verkiezingen voor de nieuwe gemeenteraad waren in maart en in juni is het nieuwe college gestart. Samen zijn we echt een fijn team, dat vanaf de start met veel energie voor Zutphen aan de slag ging. Ik ben heel blij dat dit jaar de beperkingen van corona steeds verder naar de achtergrond verdwenen. We hebben in onze gemeente weer echt de verbinding met elkaar kunnen zoeken. We hebben samen stilgestaan bij de jaarlijkse herdenkingen in onze gemeente, samen onverwachte Koninklijke onderscheidingen gevierd te midden van familie en vrienden en ook samen de handen ineen geslagen bij de opvang van vluchtelingen uit Oekraïne. In de zomer zijn we allemaal geschrokken

van een zware gasexplosie waarbij meerdere gewonden vielen en een heel aantal woningen onbewoonbaar werd. Ik heb met de mensen daar gesproken en dat heeft diepe indruk gemaakt. Ook daar heb ik weer gezien hoe de sociale samenhang in de straat en buurt echt het verschil kan maken.”








PJ: “Het was een hectisch jaar en een bijzonder jaar. De coronacrisis nam af en werd milder. Maar het was duidelijk dat het op echt véél inwoners grote impact heeft gehad. Inwoners verloren hun geliefden. Ondernemers hadden het zwaar en gingen soms failliet. Hoeveel projecten er ook doorgingen binnen het gemeentehuis, hoeveel klussen er ook werden geklaard, de grootste impact was tóch dat veel inwoners twee jaar lang zware tijden hadden doorgemaakt. Dat had effect op iedereen. Op de inwoners, het bestuur, de raadsleden en ook op de ambtenaren. Op hoe mensen met elkaar omgingen. Het werd duidelijk dat wij mensen elkaar nodig hebben. Samen maken wij de gemeente Voorst. In goede en in slechte tijden!”
HOE HEEFT U HET JAAR PERSOONLIJK BELEEFD?
TH: “Het was niet altijd gemakkelijk om positief te blijven met alles wat er speelde. De nasleep van corona, de boerenprotesten, de oorlog in Oekraïne. En veel kritiek op de overheid, die ook afstraalde op de gemeente. Kritiek is gezond en houdt je scherp. Dat vind ik echt. Maar soms was het wel extreem en dat helpt niemand. Ik vind het belangrijk ook oog te blijven houden voor het ‘stille midden’, in goed contact te blijven met onze inwoners. Er gebeuren ook zoveel goede en mooie dingen, door en voor onze inwoners en ondernemers. Voor ons gezin was 2022 een verdrietig jaar. Onze kleinzoon overleed vijf maanden na zijn geboorte aan een aangeboren hartafwijking. Dan zakt de grond wel even onder je voeten vandaan. Ik wil er verder niet te veel



over zeggen, er zijn natuurlijk veel meer mensen die iets vergelijkbaars meemaken. Maar het zet veel in een ander perspectief.”

























RK: “Deventer herpakte zich in 2022. Dat vind ik zó geweldig om te zien. Na twee zware coronajaren was 2022 bijna een gewoon en zelfs optimistisch jaar. Het leek of we met z’n allen een inhaalslag te maken hadden: evenementen, feesten, concerten en sportwedstrijden werden voor het eerst sinds twee jaar zonder coronamaatregelen gehouden. Maar… sommigen kampen nog steeds met de nasleep van corona: mensen die nog steeds niet fit zijn, ondernemers die hun bedrijf verloren, nabestaanden die hun geliefden moeten missen door corona. Het raakt mij dat in al het optimisme van 2022, deze verdrietige verhalen nog altijd doorklinken. En we hadden in coronatijd met z’n allen goede voornemens, ideeen en plannen over het leven ná corona. Maar we doen weer als voorheen, hebben misschien weinig geleerd wat we wel van plan waren.”







AV: “Ook voor mij persoonlijk was dit een bewogen jaar. 2022 is mijn laatste jaar als

10
2022 zit er bijna op en we maken ons massaal op voor het nieuwe jaar. Wat gaat 2023
ons brengen?
Nieuwsblad Stedendriehoek was nieuwsgierig hoe de burgemeesters van de grote gemeenten binnen de regio Stedendriehoek terugblikken op het afgelopen jaar én hoe zij het komende jaar instappen. Dat doen respectievelijk Ton Heerts (TH) namens Apeldoorn, Ron König (RK) namens Deventer, Annemieke Vermeulen (AV) namens Zutphen en Paula Jorritsma
(PJ) namens Voorst aan de hand van drie vragen.
Burgemeester Ton Heerts
Oudejaarsacties! Zijdewit kaderfront Denver Sfeer en frisheid kenmerken deze keuken. Incl. 5 apparaten en moderne schouw. Vlammende 22+23+24+ 27+28+29+30+31dec. GROTE KEUKEN- BADEN VLOEREN-SHOW! 22+28+29 dec. koopavond tot 21uur Nu kopen is prijsverhoging badkamer 4325,-Vlammende OudejaarsPrijs! PAUL ROESCHER TRENDline Elders 9085,3995,-Vlammende OudejaarsPrijs! Normaal 7495,+ + Hippe mediterraanse wellness badkamer Topkwaliteit keuken incl. 5 wereldtopapparaten. Boordevol noviteiten met kooken bakfaciliteiten van een echte profkok. Kookplaat met geïntgegreerde afzuiging, combi-oven en een extreem grote koelkast. Met 20 jaar garantie op het scharnierwerk en ladewerk. Leverbaar in 20 kleuren en frontvarianten, zoals: • hoogglans • mat • houtlook • beton & concrete look Koeltoren adv.prijs 1599,Combi-oven / magnetron 1000 W adv.prijs 1499,Vaatwasser met Airdry droogsysteem, adv.prijs 1050,Inductiekookplaat met geïntegreerde afzuiging 77 cm, adv.prijs 3400,+ + + + 7995,Oudejaarsprijs!: géén 16.950,- Incl. 5 apparaten en Qualitec werkblad Tot wel 60% voordeliger dan elders! Keuken Wijziging in maten en samenstelling apparatuur is mogelijk. U mag reserveren voor latere levering. Geen aanbetaling. Kies voor duurzaam en energiebesparing in uw badkamer. Binnen 1 minuut warm. en alleen wanneer u het nodig hebt. 295,-Vlammende OudejaarsPrijs! Infrarood verwarming 1645,Elders 3330,Vlammende OudejaarsPrijs! Incl. fornuis pluspakket t.w.v. €159,p/m 2565,Van 4020,- nu Vlammende OudejaarsPrijs! Richmond 900 inductie Inclusief gietijzeren pan. Naar keuze ook leverbaar in gasuitvoering. A/A 3-in-1 kokendwater-kraan Nu met Quooker zeeppomp! Totaal voordeel tot wel €345,DEMO 699,-Vlammende OudejaarsPrijs! Toilet Duravit Starck Me Randloos, compleet. DEMO Normaal 1053,10 jaar garantie op reservoir. Duurzaam: geschikt voor 4,5 liter spoeling. Draadloos telefoon laadstation adv.prijs 150,Kookworkshop t.w.v. 70,- van onze profkok 1195,Van 1395,Vlammende OudejaarsPrijs! Juice bar - DEMO Een kokend-water kraan, die ook gekoeld water geeft, desnoods met bubbels en waar je ook met een druk op de knop cola of thee uit tapt. Kookplaat met afzuiging 83cm. Inclusief flexzones, brugfunctie en luxe slidebediening. A+ Deze keuken is INCLU SI EF al het comfort en de luxe van deze 5 apparaten! Topkwaliteit PVC vloer 49,95Elders 69,95 p/m2 Incl. egaliseren & leggen door ons professioneel stoffeerdersteam. 2750,Normaal 3085,Vlammende OudejaarsPrijs!
Burgemeester Annemieke Vermeulen
het nieuwe jaar 2023 in














ontmoet. In de eerste maanden bezocht ik elk dorp en ontmoette daar veel inwoners. Wat ik bijzonder vond én vind is dat mensen zo snel voor een nieuwkomer open staan. Echt, mensen delen wat op hun hart ligt en nemen mij in vertrouwen. Als burgermoeder geeft mij dat hoop; hoop dat wij er met elkaar in deze vaak zware tijden wel doorheen komen. Samen moeten we het doen. Samen staan we sterk. In tijden van crises is dat echt zo.”












HEEFT U NOG GOEDE VOORNEMENS EN WAT STAAT ER MET VOORRANG OP DE GEMEENTELIJKE AGENDA VOOR 2023?









burgemeester van Zutphen. Dan kijk ik niet terug op één jaar, maar op zes jaar tegelijk. Ik heb genoten van een prachtige periode in een geweldige stad, waarvan ik de inwoners echt in mijn hart heb gesloten. Het doet me dan ook ontzettend goed dat ik zoveel mooie reacties heb gekregen nadat mijn aanstaande vertrek bekend werd. Ook in de regio Stedendriehoek heb ik met veel plezier gewerkt om samen de krachten te bundelen en onze regio op de politieke agenda te krijgen. Als individuele gemeente is het zoveel moeilijker om een vuist te maken, daar heb je echt de grotere schaal in de regio voor nodig. Ik neem met gemengde gevoelens afscheid, graag was ik nog langer gebleven om onze Zutphense uitdagingen verder te brengen.”



PJ: “Dit jaar was een bijzonder jaar voor mij. Ik werd burgemeester van de gemeente Voorst. Hiervoor was ik wethouder in de gemeente Altena. Samen met mijn gezin ben ik deze zomer dus verhuisd. Wij wonen nu in Twello. Mijn ontvangst en aanstelling als burgemeester waren echt bijzonder. Maar vooral warm. Ik heb in korte tijd al zóveel lieve en bijzondere mensen
TH: “Net als afgelopen jaar ben ik van plan om me ook in 2023 iedere dag weer in te zetten voor een veilig Apeldoorn, waar voor iedereen kansen zijn om iets van het leven te maken. Voor de één gaat dat wat makkelijker dan voor de ander. En ik hoop dat we juist het verschil kunnen maken voor de mensen voor wie de dingen niet altijd vanzelfsprekend gaan.”

RK: “In Deventer gaan we door op de ingeslagen weg. We blijven oog houden voor inwoners die op de een of andere manier niet of moeilijk mee kunnen doen, bijvoorbeeld door hun financiële situatie, hun gezondheid of andere zorgelijke omstandigheden. In 2022 hebben we wegen gevonden om hen te helpen. Die helpende hand steken we ook in 2023 uit. Op het gebied van woningbouw is Deventer ambitieus en we zitten vol goede ideeën voor projecten in Steenbrugge, Keizerslanden, De Kien en rond het oude stadscentrum. Dat ziet ook het Rijk, en mede om die reden hebben wij een forse subsidie gekregen om de infrastructuur van Deventer klaar te maken voor de toekomst. 2023 is het Hanzejaar, dat Deventer en andere Hanzesteden uitbundig zullen vieren. Op cultureel gebied vormen de vernieuwing van het Burgerweeshuis en die van de schouwburg belangrijke onderwerpen in 2023. Als









regio Stedendriehoek zetten we in 2023 stevige stappen in de samenwerking. Daarbij zijn wonen, werken en bereikbaarheid belangrijke thema’s. In Deventer zie ik elke dag weer dat oud en nieuw goed samengaan. Deventer kan bogen op haar eeuwenoude historie. Maar we hebben nog véél meer toekomst-eeuwen in het vooruitzicht liggen. Dat vraagt van ons allen, om verantwoord bij te dragen aan onze stad en aan onze dorpen.”






AV: “Voor mij persoonlijk staan er geen voornemens maar acties op de agenda! Ik ga op zoek naar een functie waar ik weer zoveel van mezelf in kwijt kan, dus ik richt me vooral op de toekomst en een nieuwe uitdaging. Voor de gemeente betekent 2023 een jaar waarin ze op zoek gaat naar een nieuwe burgemeester die hopelijk net zoveel plezier beleeft aan deze bijzondere post!”













PJ: “Mijn voornemen is om zelf nog bewuster met onze aarde om te gaan. We hebben maar één planeet. Daar moeten we het allemaal mee doen. Het wordt mij steeds duidelijker dat iedereen zijn of haar verantwoordelijkheid daarin moet nemen. Veel kleine daden bij elkaar geven groots effect! Maar er zijn óók grootse stappen nodig. Daarvoor moet de (rijks)overheid soms moeilijke keuzes maken. Ook de vervuilende industrie moet nu echt doorpakken. Niet alleen praten maar doen! Zelf fiets ik bijna overal naar toe. Zeker als het fietsbare afstanden zijn. En








vliegen? Dat sla ik tegenwoordig zoveel mogelijk over. Deze zomer ging ik met de trein naar Frankrijk. En dat was prima te doen en ook echt erg leuk. Ook vind ik het belangrijk om goed contact te houden met onze naaste buren: de gemeenten Deventer, Apeldoorn en Zutphen. Samen met hen vormt de gemeente Voorst een uniek gebied in Gelderland. Tussen de Veluwe en de IJssel. En áán de IJssel. Ik vind het belangrijk dat wij dit unieke gebied samen koesteren. Ieder vanuit zijn eigen sterke punten. Want ook hier geldt: alleen ga je sneller, samen kom je verder!”









































































11
Burgemeester Ron König
Oudejaarsacties! Met Megastores in: Rijssen: (7463 PH) Plaagslagen 2, (0548) 540 340 Apeldoorn: (7317 AN) Vlijtseweg 196, (055) 360 1747 PAUL ROESCHER KEUKEN•BAD•VLOER•KAST Zon/feestdagen gesloten. COMBI -VOORDEEL IS NIET VAN TOEPASSING OP TRENDLINE -ASSORTIMENT Laagste-prijs garantie! Geen aanbetaling! In Rijssen en Apeldoorn vindt u het Roescher TotaalConcept: 17.500 m2 woonplezier! 84% van de klanten beveelt Paul Roescher aan! Aangepaste openingstijden: • do 22 dec. 9-21 uur • vrij 23 dec. 9-18 uur • zat 24 dec. 9-16 uur • 25+26 dec. gesloten • di 27 dec. 9-18 uur • woe 28 dec. 9-21 uur • don 29 dec. 9-21 uur • vrij 30 dec. 9-18 uur • zat 31 dec. 9-15 uur • zon 1 jan. gesloten • ma 2 jan. gesloten prijsverhoging van 2023 ontlopen! 59,95 Elders 79,95 Vlammende OudejaarsPrijs! Tot 160 cm breed. 1750,-Vlammende OudejaarsPrijs! PAUL ROESCHER KEUKEN•BAD•VLOER•KAST COMBI-VOORDEEL Keuken incl. 5 apparaten 7995,Badkamer 4440,- -/- 10% 3995,43 m2 tegelvloer 60x120 cm 1505,40 m2 PVC vloer 2103,- -/- 5% 1750,Grand metal deur systeem 1945,- -/- 10% 1750,16.995,Alles bij elkaar + + schuifdeur = + + Badkamer compleet zoals afgebeeld •vrijstaand bad in 3 modellen •badmeubel in 6 kleuren •kranen naar keuze in 6 kleuren •wandcloset met softclosing incl. reservoir • excl. glas Wij danken u voor uw klandizie en het in ons gestelde vertrouwen in het achterliggende jaar. Directie en personeel wenst u goede Kerstdagen en een voorspoedig 2023. klanten vertellen Oudejaarsevent, noviteiten, volop live demo’s Presentaties kookplaat met afzuiging, wifi en spraakgestuurde keukenapparatuur, Jemako producten, introducties, live kokend-water kranen, 3D virtual reality ontwerpen en muzikale omlijsting. Gratis entree! leggen. Slijtvast, intensief gebruik. Flamestone vloertegel 60x120cm Topkwaliteit PVC visgraat vloer Schuifdeursysteem 60x120 cm Vlammende OudejaarsPrijs! + + Elders 56,Woonvloer 35,-Vlammende OudejaarsPrijs! p/m2 Van 74,20x120 cm Keramisch parket 20x120cm. Luxe fabrikaat met voelbare structuur. Van 1945,595,p/m o.b.v. witte deur Volledig op maat gemaakt! Elders 899,Inclusief basis interieur! Maatwerk kast Kast zonder stalen deurlijsten. Met strak afgewerkte deuren. €595,- per strekkende meter. In de kleuren Graphito, Cement en Light grey. =
in prijs dan waar ook!
Burgemeester Paula Jorritsma
Paul Roescher Lager








































 door Sabine Bootsma en Jeroen Hoek
door Sabine Bootsma en Jeroen Hoek







In Het Nationale Park De Hoge Veluwe is een populatie zeldzame wantsen gevonden. Deze wants, een insectensoort die wat weg heeft van de kever, heeft een heel specifieke leefomgeving nodig. Gelukkig voldoet De Hoge Veluwe aan de hoge eisen van dit diertje.

Het landschap van Het Nationale Park De Hoge Veluwe is erg afwisselend: van open tot dicht begroeid, van droog tot nat en van hoog tot laag. Die diversiteit biedt een geschikte leefomgeving voor heel veel verschillende planten en dieren. Het is dan

door Marc Looijen
De kop van dit artikel doet ongetwijfeld hier en daar wat wenkbrauwen fronsen. Dat kan ik me ook goed voorstellen. Het is een term van Christine, mijn personal trainer bij fit20. Die kreet ‘borstbeen aan een touwtje’ slaat op mijn houding op het toestel Lat Pull. Iets te vaak zak ik als een plumpudding terug op het zitje, terwijl er van mij een trotse houding wordt gevraagd. En hup, daar gaat mijn rechterschouder weer omhoog, mijn elleboog niet voldoende naar buiten.




ook geen toeval dat De Hoge Veluwe zo’n hoge biodiversi teit heeft. En dat zoveel zeld zame en bedreigde soorten zich daar thuis voelen. Dat gaat niet vanzelf: het Park








Gek toch, dat ik de meeste moeite heb met de trainingen Zeldzame wants gevonden op De Hoge Veluwe REDACTEUR VAN DEZE KRANT T Borstbeen aan een touwtje G.SCHRIJVER B.V. GROOTHANDEL IN OUD PAPIER, IJZER METALEN & PLASTIC FOLIE Vlijtseweg 212 7317 AN Apeldoorn Tel: 055-5216363 Al Wij betalen u een eerlijke prijs! Openingstijden: van maandag t/m vrijdag 7.30 uur tot 17.00 uur, zaterdag van 8.00 uur tot 12.00 uur 212 Apeldoorn 055-5216363 055-5211489 G.SCHRIJVER B.V. GROOTHANDEL IN OUD PAPIER, IJZER METALEN & PLASTIC FOLIE Vlijtseweg 212 7317 AN Apeldoorn Tel: 055-5216363 212 Apeldoorn 055-5216363 055-5211489 G.SCHRIJVER B.V. Vlijtseweg 212 7317 AN Apeldoorn Tel: 055-5216363 212 Apeldoorn 055-5216363 055-5211489 G.SCHRIJVER B.V. GROOTHANDEL IN OUD PAPIER, IJZER METALEN & PLASTIC FOLIE Vlijtseweg 212 7317 AN Apeldoorn Tel: 055-5216363 Al Wij betalen u een eerlijke prijs! Openingstijden: van maandag t/m vrijdag 7.30 uur tot 17.00 uur, zaterdag van 8.00 uur tot 12.00 uur GROOTHANDEL IN 212 Apeldoorn 055-5216363 055-5211489 Wij wensen iedereen fijne feestdagen en een heel gezond en gelukkig 2023 Zaterdag 24 december, maandag 26 december en zaterdag 31 december gesloten. Vanaf maandag 2 januari 2023 zijn we weer normaal geopend.












Oudejaarsactie bij Paul Roescher
APELDOORN - Paul Roescher houdt van 22 tot en met 31 december het jaarlijkse oudejaars-Event. De noviteitenbeurs staat dit jaar geheel in het teken van duurzaamheid. Centraal staan veel producten die een besparing opleveren. Direct of op lange termijn. Veel fabrikanten demonstreren hun noviteiten die tegen zeer scherpe introductieprijzen worden aangeboden. De vele koks en demonstrateurs demonstreren niet alleen de kook- en bakapparatuur, er worden ook overheerlijke gerechten bereid. Er is dus genoeg te proeven!


De oudejaarsacties zijn een jaarlijks terugkerend evenement waarbij eenmalig de mogelijkheid geboden wordt om nog te profiteren van de laatste 2022-prijzen.
Demo’s & noviteiten


Tijdens de beursdagen wordt alles uit de kast getrokken om de consument een geweldige dag te bezorgen. Er wordt gedemonstreerd met fornuizen, stoomovens,
temperatuurgestuurde inductiekookplaten, spraakgestuurde stoomapparatuur, kokendwater-kranen, en zelfs kranen waar op commando cola of thee uit komt! Te veel om op te noemen! Naast de vele interessante productinnovaties die getoond worden is er ook gedacht aan leuke activiteiten die het beursachtige karakter extra onderstrepen, zoals trucagefotografie, een poffertjeskraam, een



kunstgalerie en een live muzikale omlijsting!
Prijsvoordeel
Naast het voordeel van vele aanbiedingen tijdens de beursdagen, gelden tot en met 31 december de prijzen van 2022. Veel mensen laten zo in 2023 de keuken leveren tegen de
oude prijs. Bij Paul Roescher, een bedrijf dat ruim vijftig jaar bestaat, is dat bovendien altijd zonder aanbetaling! Een fijn stukje zekerheid. Om de almaar verdergaande inflatie een halt toe te roepen, biedt Roescher tijdens deze actiedagen een Prijs-Vastgarantie aan. Ook wanneer het pas
later in 2023 geleverd wordt, staat de prijs 100% vast.
Speciale introductie Prijspakker voor de consument is de inductiekookplaat met afzuiger. Tijdens de beursdagen is dit apparaat, dat normaal €3330,- kost, als stunt verkrijgbaar voor slechts €1645,-.
Mooi bedrag voor ontwikkeling van kinderen
APELDOORN - Leden van Rotaryclub Apeldoorn hebben vorige week een cheque van 20.000 euro overhandigd aan het Jeugdfonds Sport & Cultuur Gelderland.
Bestuurslid Aukje Sinte Maartensdijk en ambassadeur Dennis Licht namen de cheque in ontvangst in het bijzijn van wethouder Sunita Biharie.
Lopen voor het Jeugdfonds
In september liepen of wandelden 46 deelnemers via Rotary Club Apeldoorn de marathon van Berlijn. Zij
Zit

jij
Welkom







In 2022 hebben wéér meer klanten geprofiteerd van de kwaliteit/prijsverhouding van Paul Roescher! Meer dan ooit wordt de kwaliteitsformule met ‘lager in prijs dan waar ook’-prijzen gewaardeerd! Het overweldigende assortiment, de degelijke en betrokken bediening, de accurate service en de no-nonsense benadering zonder ‘gratis’ cadeautjes, sluit helemaal aan bij de huidige aandacht voor degelijk, duurzaam en recht door zee! Ook u bent van harte welkom op dit oudejaars-Event. Voor inlichtingen kunt u bellen naar 0548-530350.
De beursdagen zijn van 22 tot en met 24 en van 27 tot en met 31 december. Meer info: www.paulroescher.nl
haalden daarmee geld op voor het Jeugdfonds Sport & Cultuur Gelderland. Laura Nuhaan: “Iedereen in ons Rotary-team heeft de luxe dat we kunnen sporten. Dat willen we voor alle kinderen mogelijk maken en daarom kozen we het Jeugdfonds als goed doel.”


Samen ervaren De marathonlopers kwamen bijeen in het Loopexpertise Centrum van ambassadeur Dennis Licht, om samen met wethouder Biharie en het Jeugdfonds Sport & Cultuur



te ervaren hoe belangrijk sport & cultuur is. Wethouder Biharie: “Het is om mooi om hier de verhalen te horen. En te zien wat het Jeugdfonds Sport & Cultuur inhoudt en wat het kan opleveren. Ik vind sociale cohesie in de samenleving heel belangrijk. Samenwerken en voor elkaar zorgen, dat maakt mensen gelukkig!”
Alle kinderen doen mee Het Jeugdfonds Sport & Cultuur maakt het mogelijk dat kinderen tussen de 0 en 18 jaar uit financieel
minder draagkrachtige gezinnen kunnen sporten bij een vereniging of aan culturele activiteiten kunnen doen, bijvoorbeeld muziekles, theateractiviteiten of schilderen. Dat is belangrijk voor de persoonlijke ontwikkeling van kinderen. Ze leren samenwerken, merken waar ze goed in zijn waardoor het zelfvertrouwen groter wordt en het concentratievermogen toeneemt.
Zie ook de website www. jeugdfondssportencultuur.nl/ gelderland
Regiotaxivervoer. Wat houdt dat in?
Het betre zorgvervoer van personen die niet zelfstandig kunnen reizen met het openbaar vervoer.
Onze voertuigen staan op onze standplaats in Apeldoorn, dit is de locatie waar je dienst begint en eindigt.
Het was in de aanloop naar kerst 2003 toen Isidorus Hoeve startte met de verkoop van 100 kerstbomen ... Johnny bleek groene vingers te hebben. Het bleef niet alleen bij kerstbomen, de aanvragen voor aanleg en onderhoud van tuinen stroomden binnen. Inmiddels zijn we 20 jaar verder en hebben we een team van 28 enthousiaste hoveniers/ medewerkers. De passie voor groen heeft Johnny overgedragen aan zijn zoon Jeroen. Hij is inmiddels ook bijna 20 jaar ouder en wijzer en heeft in de jaren veel ervaring opgedaan in de branche. Jeroen is al 10 jaar een vertouwd gezicht bij Isidorus Hoeve. Tijd om het stokje van pa over te nemen. Wij wensen Jeroen hier heel veel succes mee en waar nodig zal Johnny klaar blijven staan voor hulp en advies.
• je bent in het bezit van een chau eurskaart Taxi of je bent bereid om deze te gaan behalen.
• aan een bepaalde lee ijd of opleidingsniveau hechten wij minder waarde. Enthousiasme en een warm hart voor de doelgroep en chau eur vak wel.
Heb je interesse?
Eén ding zal bij Isidorus Hoeve nooit veranderen: Uw groen is ónze passie.


Het was in de aanloop naar kerst 2003 toen Isidorus Hoeve startte met de verkoop van 100 kerstbomen ... Johnny bleek groene vingers te hebben. Het bleef niet alleen bij kerstbomen, de aanvragen voor aanleg en onderhoud van tuinen stroomden binnen. Inmiddels zijn we 20 jaar verder en hebben we een team van 28 enthousiaste hoveniers/ medewerkers. De passie voor groen heeft Johnny overgedragen aan zijn zoon Jeroen. Hij is inmiddels ook bijna 20 jaar ouder en wijzer en heeft in de jaren veel ervaring opgedaan in de branche. Jeroen is al 10 jaar een vertouwd gezicht bij Isidorus Hoeve. Tijd om het stokje van pa over te nemen. Wij wensen Jeroen hier heel veel succes mee en waar nodig zal Johnny klaar blijven staan voor hulp en advies. Eén ding zal bij Isidorus Hoeve nooit veranderen: Uw groen is ónze passie.



Wij willen iedereen bedanken voor de mooie opdrachten van de afgelopen jaren.
Fijne feestdagen en een heel gelukkig en vooral gezond 2023!
willen voor de
Fijne gelukkig
we een team van 28 enthousiaste hoveniers/ medewerkers. De passie voor groen heeft Johnny overgedragen aan zijn zoon Jeroen. Hij is inmiddels ook bijna 20 jaar ouder en wijzer en heeft in de jaren veel ervaring opgedaan in de branche. Jeroen is al 10 jaar een vertouwd gezicht bij Isidorus Hoeve. Tijd om het stokje van pa over te nemen. Wij wensen Jeroen hier heel veel succes mee en waar nodig zal Johnny klaar blijven staan voor hulp en advies. Eén ding zal bij Isidorus Hoeve nooit veranderen: Uw groen is ónze passie. Rijksstraatweg 189, 7391 MN Twello, T 0571-274926, www.hoveniersbedrijfisidorushoeve.nl
- ADVERTORIALPijnappel
OOK VOOR: SERVICE, ONDERHOUD EN REPARATIE Anklaarseweg 97A (t.o. Robur et Velocitas) 7317 AS Apeldoorn. Tel. 055 57 88 005 E-mail: info@scoot.nu
Wij leveren ook gebruikte scootmobielen met garantie. Ruime parkeergelegenheid Meer dan 20 verschillende typen scootmobielen uit voorraad leverbaar vanaf € 895,Kijk ook eens op: www.scoot.nu 15
Scoot
Scootmobielen
Wij
Rijksstraatweg 189, 7391 MN Twello, T 0571-274926,
www.hoveniersbedrijfisidorushoeve.nl
voorbij ... 2023 wordt een prachtig nieuw jaar ... ... met nieuwe blaadjes aan de bomen ... met nieuwe ontwikkelingen ... met nieuwe kansen ... met nieuwe tuinen en speelplaatsen
willen iedereen bedanken voor de mooie opdrachten van de afgelopen
feestdagen en een heel
jaren vliegen
Wij
jaren. Fijne
gelukkig en vooral gezond 2023!
Rijksstraatweg
www.hoveniersbedrijfisidorushoeve.nl
189, 7391 MN Twello, T 0571-274926,
Vragen? Bel 0412 - 676 933 of mail solliciteren@vandrielgroep.nl 24 - 40 uur per week
Chau eur regiotaxi PlusOV iets voor jou?
Solliciteer via werkenbijvandriel.nl graag achter het stuur, maar vind je het sociale aspect net zo belangrijk? En ben je gesteld op vrijheid, wil je zelfstandig werken bij een mooi
familiebedrijf met leuke collega’s? Dan zoeken wij jou! “Fijn om iemands wereld weer wat groter te kunnen maken”
Dit ben jij













































































































































































































































*Kijk op velderhof.nl/algemene-voorwaarden U vindt ons door heel Nederland: Kom naar de winkel voor het beste advies over goed zitten. Een goed (zit)advies is maatwerk. Kom naar de Velderhof winkel of maak een vrijblijvende afspraak. Bel 0499 - 729 366 www.velderhof.nl Kijk op www.velderhof.nl of bel 0499 - 729 366 *Kijk op velderhof.nl/algemene-voorwaarden. Op geselecteerde modellen. OPRUIMING Showroommodellen Wij houden onze jaarlijkse opruiming. Kortingen tot wel 70%. Profiteert u mee? 13x 17x 28x 10x 21x 14x 11x 27x 7x 9x 15x 23x 531,762,826,673,531,530,935,- 524,- 495,491,395, 721, 681,12x + Gratis Velderhof Cadeaupakket 7x 32x 22x 16x 327,- 935,- 226,- 673,22 DEC 21 DEC 20 DEC 23 DEC 24 DEC Apeldoorn Asselsestraat 34 Velp Hoofdstraat 59 Laren Brink 10D Best Koningin Julianaweg 13 NIEUW Breda Slingerweg 87 Beek Aldenhofstraat 78 NIEUW Haren Rijksstraatweg 205 Wij maken ruimte voor onze nieuwste collectie. Helpt u onze oude collectie opruimen? Dan profi teert u nu van hoge kortingen op talloze modellen uit 2022. In diverse maten, uitvoeringen, opties, bekleding en kleuren. Kom naar de winkel in Apeldoorn of Velp of bel 0499 - 729 366 voor de actuele voorraad.
Veranderingen om kwaliteit van zorg te waarborgen
Op dit moment is er bij De Graafschap Dierenartsen, net zoals in andere sectoren, sprake van een tekort aan personeel in de diergeneeskundige zorg. Tegelijkertijd is de vraag naar hoogwaardige veterinaire zorg de laatste jaren alleen maar toegenomen.
Om de kwaliteit van de zorg te kunnen waarborgen en een gezond werkklimaat voor de medewerkers te behouden, zullen er komend jaar een aantal aanpassingen doorgevoerd worden bij De Graafschap Dierenartsen: De locaties Eerbeek en Brummen worden per 1 januari 2023
samengevoegd en verhuizen per maandag 30 januari 2023 naar de nieuwe locatie aan de Loubergweg 3 te Eerbeek. Tot die tijd blijft de oude locatie Eerbeek in gebruik. Door het openen van een grote, volledig uitgeruste locatie is er een uitgebreider scala aan diagnostiek en


behandelingen mogelijk en zullen meerdere dierenartsen en paraveterinairen samen klaarstaan voor de klanten en hun huisdier.
De locatie Dieren sluit per 1 januari 2023. Helaas is het afgelopen jaar gebleken dat door een tekort aan personeel het onvoldoende mogelijk is
deze locatie open te stellen. De klanten kunnen natuurlijk nog steeds terecht bij De Graafschap Dierenartsen, bijvoorbeeld op de locaties Eerbeek, Doesburg, Velp en Zutphen. De medewerkers van de locaties Brummen en Dieren danken hun trouwe klanten voor het in hen
gestelde vertrouwen en fijne contact en zien u graag terug op een van de andere locaties waar zij werkzaam zullen zijn. Op de locatie in Doesburg zal per 1 januari 2023 de openstelling op zaterdag komen te vervallen. Om de spoedzorg in het weekend te kunnen blijven voorzien, wordt deze zorg gecentreerd op de hoofdlocatie in Vorden, Schimmeldijk 1. Hier kan men in het weekend dagelijks terecht van 8.00 tot 22.00 uur voor spoedzorg.
De Graafschap Dierenartsen gaat er vanuit hiermee te kunnen inspelen op de ontwikkelingen in de veterinaire sector. Echter,
de verwachting is dat het tekort aan dierenartsen niet op korte termijn opgelost zal zijn. Mogelijk zal dit in de toekomst leiden tot oplopende wachttijden voor nietspoedeisende zorg. Daarnaast zal het niet altijd vanzelfsprekend zijn dat men altijd op korte termijn bij de vaste dierenarts terecht kan en zal specialistische zorg niet te allen tijde beschikbaar zijn.
De Graafschap Dierenartsen is er van overtuigd met deze aanpassingen de klanten zo optimaal van dienst te kunnen zijn en tegelijkertijd de kwaliteit van de zorg te waarborgen.
Openingstijden en bezoektijden Gelre ziekenhuizen in kerstperiode
geopend en bieden ze alle noodzakelijke spoedzorg; is ook de receptie gewoon bemenst.
Tijdens de feestdagen
Openingstijden: tijdens kerst (25 en 26 december) en op Nieuwjaarsdag (1 januari) zijn de poliklinieken en
prikpunten op alle locaties gesloten en dus ook niet telefonisch bereikbaar; zijn de SEH, EHH/CCU, IC en verpleegafdelingen 24/7
Bezoektijden: Gelre staat momenteel per bezoekmoment twee bezoekers per patiënt toe. Tijdens kerst (25 en 26 december) en op Nieuwjaarsdag (1 januari) gelden de huidige bezoektijden en bezoekregels. Op Oudjaarsavond is er een extra bezoekmoment voor één persoon per patiënt tussen 22.00 en 01.00 uur. Deze bezoeker mag dus 3 uur bij zijn geliefde/naaste in het ziekenhuis verblijven.
Overige dagen in de
kerstvakantie
Openingstijden en telefonische bereikbaarheid: een aantal afdelingen heeft ook op andere dagen dan met kerst aangepaste openingstijden of een andere telefonische bereikbaarheid. Dat gaat om de hieronder genoemde afdelingen.
Prikposten: check voor de actuele openingstijden van alle prikposten in het prikpostenoverzicht de website.
Polikliniek Epe: week 52 (26 december tot en met 1 januari) gesloten.
Afdeling Verloskunde en Vrouw & kindcentrum in


Zutphen: tijdens de feestdagen (24, 25, 26 december en 31 december en 1 januari) zijn deze afdelingen doorlopend te bezoeken. Buiten deze dagen gelden de reguliere bezoektijden.
Indien er vragen over de bezoek- of openingstijden zijn, is via de website de actuele informatie te vinden: www.gelreziekenhuizen.nl.

Ook kan contact opgenomen worden met de betreffende afdeling. Als de afdeling op dat moment niet bereikbaar is, bel dan het algemene nummer. Bel 055-5818181 voor Gelre Apeldoorn en 0575592592 voor Gelre Zutphen.
Met kerst laten we niemand in de kou staan
De decembermaand vraagt om mensen die omkijken naar een ander. Die klaarstaan voor mensen in moeilijke omstandigheden hier in Nederland en wereldwijd. Laat niemand in de kou staan. Help ook mee en doneer aan het speciale Kerstfonds van Cordaid. Iedere bijdrage is welkom. Met uw gift zorgen we voor directe noodhulp en structurele oplossingen als gezondheidszorg, veiligheid, scholing en werk.
Zoals in Oekraïne, waar het tien maanden na het begin van de oorlog duidelijk is dat het land zich in een aanhoudende humanitaire crisis bevindt. De stijgende prijzen voor voedsel en energie verergeren de situatie. En dat is echt een enorm probleem, zeker nu de temperaturen extreem dalen. Cordaid is al begonnen om de kapotte huizen te repareren. Maar door de barre winter kunnen mensen het nog moeilijk warm houden. Zij hebben dringend behoefte aan dikke kleding, dekens en (warm) water.

Ook dicht bij huis zijn er mensen die dagelijks te maken hebben met armoede of eenzaamheid. Denk hierbij aan thuis- en daklozen, die deze winter op straat moeten zien te overleven. Maar ook aan mensen die door de energiecrisis en de stijgende kosten te maken krijgen met schulden en in een isolement terecht zijn gekomen. Cordaid ondersteunt het werk van Schuldhulpmaatje zodat mensen zelf de kans krijgen aan hun toekomst te werken.
Cordaid strijdt voor een wereld zonder armoede waarin iedereen een menswaardig leven heeft, in Nederland en wereldwijd. Wij werken in de moeilijkste omstandigheden met mensen die getroffen zijn door oorlog en conflict, onrecht of natuurrampen. Wij geloven in de kracht van mensen om hun leven -opnieuw- op te bouwen en er ook voor elkaar te zijn.
- ADVERTORIAL19
KIJK OOK OM NAAR EEN ANDER SCAN DE QR-CODE EN GEEF AAN ONS SPECIALE KERSTFONDS
www.cordaid.nl/kerst
APELDOORN/ZUTPHEN - De feestdagen staan voor de deur. Wat betekent dit voor de openingstijden en bezoektijden binnen Gelre ziekenhuizen?





















Vrijdag 23 december openen wij onze geheel vernieuwde winkel in Apeldoorn. En dat vieren we! *Alleen geldig op vrijdag 23 en zaterdag 24 december 2022 in de winkel. Actie geldt niet in de webwinkel en niet geldig op reeds afgeprijsde artikelen. Kijk voor de voorwaarden op welkoop.nl/openingen. Druk- en zetfouten voorbehouden. Welkoop Apeldoorn Laan van Spitsbergen 89, 7336 AR Apeldoorn vrijdag 23 en zaterdag 24 december 20% korting op alles* 2 dagen lang
Voetbalacademie heeft trainersstaf voor nieuwe seizoen rond
De Go Ahead Eagles
Voetbalacademie heeft voor het seizoen 2023/2024 de zes functies van hoofdtrainer ingevuld. Alle hoofdtrainers voor het aankomende seizoen zijn stuk voor stuk jeugdtrainers die ook in het huidige seizoen al actief zijn binnen de jeugdopleiding van de club.

“Onze hoofdtrainers vervullen uiteraard een belangrijke functie binnen de Go Ahead Eagles Voetbalacademie”, zegt Eric Whittie, hoofd jeugdopleiding bij Go Ahead Eagles. “We zijn dan ook blij dat de namen van de zes hoofdtrainers voor het seizoen 2023/2024 op dit moment al bekend zijn. Het stemt ons extra tevreden dat sommigen van hen zich zelfs voor meerdere jaren aan de Go Ahead Eagles Voetbalacademie hebben verbonden.”
“Daarnaast zijn we op dit moment druk bezig met de invulling van de rest van de begeleidingsstaf.
In de Go Ahead Eagles Voetbalacademie zijn zo’n 130 jeugdspelers actief, maar ook bijna honderd personen die er gezamenlijk voor zorgen dat onze talenten díe begeleiding krijgen die nodig is om hun voetbaldroom na te jagen. Assistent-trainers, performance trainers, keeperstrainers, specialisten, ondersteunende begeleiders, noem maar op. Er zit al veel schot in de gesprekken die we met iedereen voeren en binnenkort hopen we met een
totaaloverzicht van de stafindeling voor de zes verschillende jeugdteams naar buiten te kunnen treden.”
Voor het seizoen 2023/2024 zullen de volgende hoofdtrainers bij de verschillende jeugdteams voor de groep staan:
Martijn Jongbloed (momenteel hoofdtrainer Onder-21)
Jeroen Spies (momenteel hoofdtrainer Onder-18)
Jip Ellenbroek (momenteel hoofdtrainer Onder-16)
Patrick Kieftenbelt (momenteel assistent-trainer Onder16)
Peter Vogel (momenteel hoofdtrainer Onder-14)
Bram Meuwissen (momenteel hoofdtrainer Onder-13)
Aygun neemt afscheid Mustafa Aygun (hoofdtrainer Go Ahead Eagles Onder15) had al eerder besloten dat hij vanaf het seizoen 2023/2024 geen onderdeel meer uit zal maken van de staf van de Go Ahead Eagles Voetbalacademie. Dit
heeft hij kenbaar gemaakt in een gesprek met Eric Whittie, hoofd opleiding van de Voetbalacademie.
“De combinatie met mijn dagelijkse werkzaamheden en de trainingen en wedstrijden bij Go Ahead Eagles vergen ongelooflijk veel tijd”, geeft Aygun aan. “Daardoor is het soms lastig om de balans met mijn privéleven te vinden. Daar komt bij dat de uitdaging om een seniorenteam te trainen nog altijd bij me leeft, want ook dat heeft mij in het verleden veel plezier gebracht. De afgelopen
jaren heb ik als trainer veel opgestoken bij de Go Ahead Eagles Voetbalacademie en ik ervaar deze kennis als zeer kostbaar. Mogelijk dat ik op de een of andere manier alsnog betrokken blijf bij de Voetbalacademie; daarover ben ik nog met Eric Whittie in gesprek.”
Eric Whittie: “Mustafa heeft de enige juiste keuze gemaakt en die keuze verdient respect. Temeer omdat ik dagelijks
ervaar dat hij het werken bij ons heel serieus neemt en met volle overgave invult. In de gesprekken die we samen hebben gevoerd, is mij duidelijk geworden dat het plezier er bij hem absoluut nog is. Dat is mooi, want we willen dat niet alleen onze voetbaltalenten plezier hebben, maar uiteraard ook onze stafleden. Ik hoop dat Mustafa snel een mooie club vindt, want dat verdient hij absoluut.”



 Foto: Carlo Bruil
Foto: Carlo Bruil
Kerst vier je in een trui van Go Ahead Eagles


Een Noor, een Zweed en een ‘Finn’. Drie Scandinaviërs op zoek naar de ultieme kerst-


21
sfeer. Én op zoek naar Harly. Want waar de clubmascotte van Go Ahead Eagles is gebleven, is voor hen een groot raadsel. Flying home for Christmas, wellicht?
De Eagles Kersttrui die Oliver Edvardsen, Isac Lidberg en Finn Stokkers dragen, is te koop in de Fanstore of webshop. Zolang de voorraad
vuurwerkvrijapeldoorn.nl Apeldoorn telt af! Kom naar de aftelfeesten en vier de jaarwisseling samen! Zuiderpark Droneshow 17.00 -19.00 uur Zwitsalterrein Vuurwerkshows 20.30 - 01.00 uur Dorpshuis Uddel Vuurwerkshow 21.30 - 23.30 uur Go Ahead Eagels
strekt. De prijs is €44,95. Er zit een pluche bal aan de voorkant van de trui als ‘red nose’ van Harly. De trui is 100% polyester en valt klein uit (aansluitend model, vooral bij de armen)
DUURZAME WARMTE
Het duurzame hart van… Jelle Visser

Ook de gemeente Apeldoorn vindt duurzaamheid belangrijk. Daarom maken we vaart met besparing en opwek van duurzame energie. Er zijn óók veel inwoners die zich inzetten voor een duurzame toekomst. In deze rubriek vertellen mensen die hier op hun eigen manier mee bezig zijn. Dit keer is dat Jelle Visser uit Apeldoorn.
Wie bent u en wat doet u? Ik ben Jelle Visser en ik werk sinds 11 jaar als leraar (stamgroepleider) op Jenaplanschool De Ontdekking. Ik geef les aan een gecombineerde klas, groep 6, 7 en 8. In onze groep geven wij vaak les aan de hand van thema’s. Eén van die thema’s is het programma van de Junior Energiecoach. Dit is een programma waarin kinderen leren om bewuster met energie om te gaan. Dit leren ze door thuis een aantal opdrachten te doen.
Waar gaat uw duurzame hart sneller van kloppen?
Mijn duurzame hart gaat sneller kloppen als ik met de kinderen over duurzaamheid praat. Kinderen kijken op een heel andere manier naar de wereld. Het ene moment maken ze zich druk om grote bedrijven die alleen maar winst willen maken en dus niet goed zijn voor de wereld. En het andere moment spelen ze lekker buiten.
Meedoen met de Junior Energiecoach? Dat kan!
De Junior Energiecoach is voor kinderen van 7 tot 12 jaar. In de klas gaan leerkracht en leerlingen wekelijks op een speelse en praktische manier aan de slag met energiebesparing. Goed voor het milieu én goed voor de portemonnee.


De leerkrachten zijn er wekelijks zo’n twintig tot dertig minuten mee bezig. En de opdrachten worden vooral thuis gedaan. Zo gaan de kinderen bijvoorbeeld op lampenjacht, ontdekken ze hoe ze lol kunnen maken zonder energie en leren ze wat CO2-etende steentjes zijn.
Enthousiast geworden en wilt u meer informatie? Ga dan naar de website www.juniorenergiecoach.nl
Aanmelden kan tot 7 februari 2023 via de website.
Waar komt uw eigen motivatie voor duurzaamheid vandaan?
Ik heb het van huis uit meegekregen. En ik hou enorm van de natuur. Wat mij opvalt bij de kinderen in mijn klas is dat ze willen dat oudere generaties letten op hun toekomst. En dat we doen wat in onze macht ligt. Dat kan mij best raken, want op veel zaken hebben zij zelf geen invloed.
Wat vonden de kinderen van de Junior Energiecoach?
De reactie van de kinderen was over het algemeen positief. De kinderen zijn gek op de filmpjes van Varkentje Rund, want dat kennen ze van Het Klokhuis. De opdrachten van de Junior Energiecoach hebben heel wat gezinnen in beweging gebracht. Dat merkte ik toen één van de opdrachten was om thuis een lampenspeurtocht te houden.
Door dit soort opdrachten merk je dat kinderen al spelend bewuster worden. Ze doen vaker de deuren dicht tegen de tocht, ze doen vaker de lichten uit en gaan meer buiten spelen vanwege de frisse lucht.
Er waren natuurlijk ook kinderen die er thuis niet heel veel mee deden. En dat is ook goed. Niet iedereen wordt enthousiast van elk thema.
Hoe heeft u het lesprogramma zelf ervaren?
Het programma was heel goed uit te voeren. De kinderen hebben er zin in, er is genoeg om over te praten en er is ruimte om door te pakken. Het valt ook heel erg mee hoeveel tijd het kost. Je kan al starten met minimaal dertig minuten per week en je kan zelf kiezen hoe je het wilt uitbreiden.
Hoe hebben de ouders gereageerd?
Ik heb er niet veel gesproken, maar er waren wel enthousiaste ouders die het programma erg konden waarderen. Duurzaamheid is natuurlijk een hot item. Er zijn best veel ouders die zelf ook wel willen verduurzamen, net als ik. Dat hun kinderen hier dus veel over leren en hen ook weer kunnen meenemen, vinden ze eigenlijk best leuk.
Wat is uw duurzame tip?
Mijn duurzame tip is inzicht krijgen in je eigen handelen. Daar begint het wat mij betreft mee. Weten welke mogelijkheden er zijn, zoals het gebruik van LED lampen of het goed inregelen van je cv-ketel. Weten hoeveel je dagelijks verbruikt aan stroom en water kan enorm bijdragen aan veranderingen.
Prijsplafond
Vanaf 1 januari 2023 start het prijsplafond van de energierekening. Dit betekent dat u tot een bepaald verbruik niet meer betaalt dan een maximale prijs voor gas en stroom. Door dit prijsplafond krijgen de meeste huishoudens korting op hun energierekening.
Wilt u weten hoe dit er voor u uit gaat zien?
Kijk dan op de website van de Rijksoverheid: www.rijksoverheid.nl (zoekwoord: prijsplafond).
Energiezuinig de kerst door
Met kerst pakken de meeste mensen graag uit. Met lekker eten, mooie kleding en gezellige versiering. Maar hoe viert u dit een stukje duurzamer? Hierbij wat tips.
Wist u dat kerstlampjes van ledverlichting ongeveer acht keer zuiniger zijn dan kerstverlichting met gloeilampjes? De moeite waard om even te kijken wat er in uw boom hangt. En bent u na dit jaar toe aan nieuwe kerstversiering? Ruil uw kerstspullen met uw beste vriend(in), buur of familielid. Zo bespaart u nieuwe kerstdecoratie die de rest van het jaar op zolder staat.

Meer duurzame tips leest u op de website www.milieucentraal.nl. Kies een paar dingen uit en doe volgend jaar weer een stapje extra!
Openingstijden Energiepunt
In de kerstperiode heeft het Energiepunt aangepaste openingstijden:
Open op:
• Woensdag 28 december t/m vrijdag 30 december
• Vanaf 2 januari open volgens de normale openingstijden
Gesloten op:
• Zaterdag 24 december t/m dinsdag 27 december
• Zaterdag 31 december en 1 januari
APELDOORN OP WEG
NAAR
www.apeldoorn.nl/duurzamewarmte
Feestdagen


Silvester keek alvast vooruit naar het nieuwe jaar en ontdekte een jubileum. Hij stuurde me een lief appje met de tekst: ‘Volgend jaar zijn we 25 jaar bij elkaar.’ Hij praat vaker tevreden over de duur van onze langlopende relatie. Ik denk dat het komt omdat zijn beide ouders meermaals zijn gescheiden en hertrouwd.


hoofd? We wisten het niet meer. Silvester wist er nog een positieve draai aan te geven en zei: ‘Stel je voor dat we dit pas volgend jaar hadden ontdekt. Dat was pas écht erg geweest!’ Lacherig stelden we vast dat we tenminste nog in het goede jaar beseften dat we een jubileum hadden gehad.



Vijfentwintig jaar samen... We bespraken hoeveel geluk we hebben gekend, en hoeveel liefde.

We hebben zware jaren gehad en gemakkelijke jaren. Eigenlijk precies wat iedereen altijd over het huwelijk zegt. Maar het is gelukt, we zijn nog altijd tevreden samen.
HET WAS ONGEMERKT VOORBIJGEGAAN
Ieder jaar erbij is voor hem speciaal, zeker nu het een serieuze lengte begint te worden.
Glimlachend rekende ik met hem mee, maar ik moest terug appen: ‘Nee, het was dít jaar! We zijn al 25 jaar samen!’
Wanneer leerden we elkaar ook alweer kennen? In de lente van 1997… Ja, zie je!


Het jubileum waar we naar uitkeken, was al ongemerkt voorbijgegaan!

Hoe konden we dit vergeten? Waar zaten we het afgelopen voorjaar met ons
Op de valreep gaan we het alsnog vieren – in het goede jaar. De kerstdagen hebben we omgedoopt tot feestdagen vanwege ons huwelijksjubileum.

Alles waarvoor we de kinderen hebben uitgenodigd, heeft als reden gekregen dat we zoveel jaar verkering hebben. Vijfentwintig jaar en zeven maanden maar liefst.
Tevreden stelden we vast dat we samen nog hardop kunnen lachen. Dus ja, wat wil je nog meer?

Dit viel mij op






Het interesseerde me niet, maar toch was het gezellig
“Ik ben wel blij dat het WK Voetbal voorbij is. Eigenlijk interesseerde het me niets, maar ik merkte dat ik steeds vaker voetbal op had staan. Als behang, weet je wel?
Ik vond het gezellig op mijn scherm en gaandeweg begon ik zelfs dat programma te kijken met Johan Derksen, Oranjewinter.
Terwijl ik helemaal niet van voetbal hou! Dat is toch
erg? Maar ja, ik keek dus wel. Ook de wedstrijden van andere landen liet ik opstaan. Toen Nederland eruit lag, ben ik mee gaan juichen voor Marokko. Dat was wel leuk, het was gezellig. Maar nu kan ik tenminste mijn eigen dingen weer doen, de dingen waar ik wél van hou.” – Sabine
Is jou ook iets opgevallen? Stuur het in ca. 10 regels naar nanda@stedendriehoek.nl, o.v.v. ‘dit viel mij op’.

































Ik wil een bomvolle kersttafel!
Regina, 40 jaar, Deventer: “Mijn man kan mooi decoreren en die pakt helemaal uit. Dat wordt altijd erg mooi. Soms hebben we speciaal dennenappels uit het bos zilver gespoten. We maken ook altijd kerststukjes met de kinderen, dat is ook een heel leuke vakantie-activiteit natuurlijk. Zo komt het kerstgevoel wel. Het is bij ons soms net of je een decoratiewinkel binnenloopt. Het is versierd met dennenappels en soms met glitters of kerstballetjes erbij. Soms hangt mijn man dingen in de lamp... Hij kan het echt heel knap.”




Juliëtte, 40 jaar, Deventer: “De decoratie vind ik heel leuk. Het hoeft niet heel uitgebreid, maar het is wel leuk om de tafel even netjes te dekken. Maar het hoeft niet perfect als een, weet ik veel, als in een Hilton hotel. We hebben vooral lekkere kleine hapjes, zodat je lekker kunt kletsen en een beetje kunt snacken tussendoor. Iedereen neemt wat te eten mee en daar kun je de hele avond lekker wat van pakken. Een lopend buffetje maken, dat vind ik geniaal.”
Ganna, 45 jaar, Apeldoorn: “Een tafel met zoveel mogelijk vrienden en zoveel mogelijk eten. Bij de kerstdecoraties ben ik wel van het moderne: dat er één groot item mag staan en dat er heel veel lichtjes zijn – zoveel mogelijk. Ik ben niet van hier nog kerststukje en daar nog wat ballen. Nee, ik hou niet van die kleine prutjes. Ik ben van de grote items: more is less en less is more. Maar wel graag met heel veel lichtjes. Het witgele licht dat heel geraffineerd overal doorheen blingt.”

23 COLUMN NANDA ROEP
vuurwerkvrijapeldoorn.nl Apeldoorn vuurwerkvrij dat siert ons SPAAR MEE! EN GA VOOR 12,50 NAAR HET WINTERCIRCUS VOORDELIG NAAR HET WINTERCIRCUS MET JUMBO APELDOORN DE OUDE OLIFANTENSCHUUR FRUITBEDRIJF BOUWMAN Bij paleis het Loo. De hele maand december: * Stoofperen Gieser Wildeman voor € 1,-/kilo * Goudreinet voor € 1,-/kilo Heerlijke ouderwetse APPELBOLLEN van eigen appelen, vers ter plaatse bereid door een echte bakker. Tuinmanslaan 24a in Apeldoorn woensdag t/m vrijdag van 13.30 tot 17.30 zaterdag van 9.00 tot 16.30 uur Word nu lid op natuurmonumenten.nl en ontvang 4 x per jaar het magazine Puur Natuur WE KUNNEN NIET ZONDER NATUUR














































































































7 dagen per week open dichtbij Utrecht, direct aan de A12 * niet geldig i.c.m. andere acties/aanbiedingen NIEUW! zitbank BELLAGIO in div. opstelling en stoffen. 2,5 zits VANAF 1699.Op voorraad Vitrinekast CARLOS afm. 90 x 191 x 40 cm NU 549.Daybed CANNES in div. stofsoorten NU VANAF 899.NIEUW! Fauteuil HARTFORD incl hocker NU 449.Op voorraad Fauteuil in beige of olijfgroen NU 349.SFEERVOL KERSTSHOPPEN VAN eijerkamp. BIJ SNEL IN HUIS! Eetkamer stoel INAYA in div. kleuren NU 329.ZA 24 DECEMBER 10.00 - 17.00 ZO 25 DECEMBER gesloten MA 26 DECEMBER 11.00 - 17.00 DI 27 DECEMBER 10.00 - 17.30 WOE 28 DECEMBER 10.00 - 17.30 DO 29 DECEMBER 10.00 - 17.30 VRIJ 30 DECEMBER 10.00 - 17.30 ZA 31 DECEMBER 10.00 - 17.00 1 e Kerstdag Kerstdag KERSTCADEAU: WOONCHEQUES TOT 500.- VOORDEEL In onze extra sfeervolle winkels ligt nu een feestelijke envelop voor je klaar met wooncheques tot 500.- voordeel* Kom woonshoppen en laat je verrassen door de nieuwste wooncollecties en profiteer nu nog van de prijzen van 2022! SNEL IN HUIS! Eettafel RHOMBIC in div. afmetingen VANAF 499.op voorraad Op voorraad Eetkamerstoel BOUCL É in diverse kleuren 199.95 Bergkast GRAVURE 699.- Hanglamp ROLF VAN 259.- VOOR 207.-
APELDOORN - In de Victorkerk aan de Jachtlaan 187 vindt zaterdag 24 december vanaf 19.30 uur de kerstzangavond plaats. Het thema van de dienst is ‘Vrede op aarde’.
Na twee coronajaren met gestreamde kerstdiensten is dominee A.A.F. (Alfred) van de Weg blij dat deze samenkomst weer daadwerkelijk fysiek kan plaatsvinden. “Het thema Vrede op aarde is natuurlijk klassiek, maar door onder andere de oorlog in Oekraïne weer erg actueel. We belichten de vrede horizontaal, dus van mens tot mens, maar ook verticaal: de vrede tussen God en de mensen. Verder is het



APELDOORN - Meer dan ooit wordt contact gezocht met de Luisterlijn. Dag en nacht bieden vrijwilligers een luisterend oor aan mensen met pijn, verdriet en zorgen. Binnenkort start er een training voor nieuwe vrijwilligers in de Stedendriehoek. De Luisterlijn zoekt mensen die hieraan mee willen doen, want nieuwe vrijwilligers zijn hard nodig.

Het aantal oproepen bij de Luisterlijn blijft onverminderd hoog. In 2021 voerden vrijwilligers meer dan 350.000 gesprekken, via telefoon en chat. Eenzaamheid is vaak een reden waarom mensen

een vertrouwd concept met prachtige muziek, het zingen van kerstliederen en een appèlwoord van mij. Iedereen is welkom in de kerk. Wie verhinderd is, kan de dienst
volgen via een livestream: hhgapeldoorn.nl/kerst/”


De Victorkerk telt zo’n zevenhonderd gemeenteleden, van wie het merendeel weer de
twee kerkdiensten op zondag bezoekt: ’s ochtends om 09.30 uur en ’s middags om 16.30 uur. “Nog steeds verkiezen sommige gemeenteleden om de diensten thuis te streamen, maar dat was vóór corona ook al het geval. Het afgelopen jaar hebben we in de kerk ook nieuwe gezichten mogen begroeten. Zij kwamen soms uit andere kerken maar soms ook uit andere tradities. Zo is één mevrouw bijvoorbeeld vanuit de RoomsKatholieke kerk naar onze gemeente gekomen”, aldus Van de Weg. “Ieders leven stond op z’n kop in coronatijd. We zochten allemaal naar houvast in een tijd van onvastheid. Dat zoeken we in het Woord van God:

geloofszekerheid, de hoop op het eeuwige leven. Ik heb zeker de afgelopen twee jaar in dat kader veel persoonlijke gesprekken gevoerd met leden van onze gemeente.”
De dominee verheugt zich er zichtbaar op om het kerstevangelie weer te mogen prediken. “Het blijft een mooi verhaal. Dat God een weerloos kind naar de mensen heeft gebracht, dat zorgde voor een revolutie in de wereld, zonder maar enige vorm van manipulatie. Hoe anders is dat tegenwoordig met de reclameboodschappen die je om de oren vliegen.” In coronatijd schreef Van de Weg het boekje ‘Daarom ga ik naar de kerk’,


met - letterlijk - tussen de regels door: Gedachten over Gods huis als plaats van ontmoeting. “De kerk als plek die anders is dan alle andere plaatsen. De plaats waar ik God aanroep.” De dominee heeft in de coronajaren het gemeenschapsgevoel gemist, en zeker ook het samen zingen in de kerk. “Het is fijn dat dit alles nu weer terug is en dat we ook volgend jaar kunnen doorgaan met de kerkdiensten en overige activiteiten, zoals het inloophuis op vrijdagochtend en de kinderbijbelclub. Dat we echt weer die ontmoetingsplaats kunnen zijn voor onze gemeenteleden en de buurt.”

Voor meer informatie: www. victorkerk.nl

Vrijwilligers bij de Luisterlijn zien het als een groot pluspunt dat ze zelf hun diensten kunnen inplannen en deze vanuit huis kunnen doen.
contact opnemen. Om alle oproepen te kunnen beantwoorden, zijn er dringend
nieuwe vrijwilligers nodig. Zij krijgen hiervoor een professionele training en begeleiding.


Geen saai werk Vrijwilligerswerk bij de Luisterlijn is niet gemakkelijk, maar zeker ook niet saai. Ieder gesprek is anders, vertelt Joke, een van de vrijwilligers: “Als ik dienst heb, is het elke keer weer een verrassing waar mensen graag over willen praten. Soms voelt iemand zich erg eenzaam, of er is ruzie binnen de familie. Maar het kan ook gaan over een nieuwe jurk. Iedereen heeft op zijn tijd behoefte
aan een luisterend oor of een goed gesprek. We hebben tijd en aandacht voor het verhaal van de ander. Je loopt als het ware even met elkaar op en door erover te praten, komen mensen vaak tot nieuwe inzichten. Dat is zo mooi, daar geniet ik iedere keer weer van!”
Aanmelden als vrijwilliger De Luisterlijn maakt graag in januari en februari kennis met nieuwe vrijwilligers. Daarna start op vrijdag 3 maart de training. Hierin staan gespreks- en luistervaardigheden centraal. Kijk voor meer informatie op de website www.deluisterlijn.nl/
vrijwilligerswerk. Men vindt daar ook meer informatie over de training en begeleiding.
Over de Luisterlijn
De Luisterlijn is al zestig jaar dé organisatie in Nederland die het hele jaar door 24/7 een luisterend oor biedt. Vanuit verschillende locaties in het land voeren zo’n 1.500 vrijwilligers dag en nacht ruim 350.000 anonieme gesprekken per jaar, via telefoon en chat. Door te luisteren helpen zij mensen om zorgen, pijn en verdriet (even) het hoofd te bieden. De vrijwilligers krijgen een professionele training en worden doorlopend begeleid.
25 MASTERPIECES.NL • NIEUWSTRAAT 53 • 7411 LH DEVENTER Volg en like ons op: facebook.com/masterpieces.nl WITTE KERST DIT JAAR? SNOWBALL VAN EDGE SCULPTURE LIMITED EDITION
Kerstzang in de Victorkerk rond vrede op aarde De Luisterlijn kan ‘nieuwe oren’ goed gebruiken Elke dag een 10 minuten workout DISQ apparatuur t.w.v. € 199,Start met je 21 dagen challenge Gratis E-book met voedingsplan Drie maanden toegang tot onze online gym WINTERDEAL WINTER DEAL 239,95 99,95
































DONDERDAG DECEMBER 09.30 - 17.30 WOENSDAG NOVEMBER 09.30 - 17.30 130 VRIJDAG DECEMBER 09.30 - 17.30 2 ZATERDAG DECEMBER 09.30 - 17.00 3 ZONDAG DECEMBER 12.00 - 17.00 4 LEEGVERKOOP LEEGVERKOOP TOTALE MEUBEL TERWOLDE (NAAST DE MOLEN) WIJKSEWEG 7 HONDERDEN Bankstellen Hoekbanken Tafels - Stoelen Kasten Dressoirs (Relax)Fauteuils Boxsprings Matrassen Kussens Enz.Enz 70% 70% KORTINGEN TOT DIREKT LEVERBAAR 4000 M2 Pak je kans Voormalige pand Vorderman Voormalige pand Vorderman naast de molen Terwolde Terwolde ALLES IS DIRECT LEVERBAAR Neem uw auto/aanhanger/bakfiets etc. mee (Latere levering is ook mogelijk) Enorme partij RELAX FAUTEUILS 21 decEMBER 22 decEMBER 23 decEMBER 24 decEMBER Tweede Kerstdag geopendvan11.00 tot 17.00 uur 25 decEMBER GESLOTEN
Wereldtop en lokaal talent zij aan zij op KNWU NK Baanwielrennen
APELDOORN - Wie een kaartje koopt voor het Nederlands Kampioenschap Baanwielrennen in Apeldoorn, ziet zowel de wereldtop onder de Nederlandse baanrenners als de aanstormende talenten uit de regio Apeldoorn aan het vertrek. Dit topevenement biedt de liefhebber op 27, 28 en 29 december een mooie sportieve afsluiter van het jaar. Onder anderen olympisch kampioenen Harrie Lavreysen en Matthijs Büchli verschijnen in de baan van Omnisport Apeldoorn.
Ze reden in de zomer van 2021 samen naar olympisch succes in Tokio op het onderdeel teamsprint. Maar Büchli en Lavreysen gaan in Apeldoorn de strijd niet met elkaar aan. De eerste heeft zich namelijk toegelegd op het rijden van wegwedstrijden en de duuronderdelen op de baan. Een heel nieuwe wereld voor de Noord-Hollander, alleen zijn sponsor bleef dezelfde met BEAT Cycling. Nadat Büchli de afgelopen weken al op de langere onderdelen in actie kwam in de prestigieuze Champions League van de internationale wielerbond UCI, rijdt hij op het KNWU NK Baanwielrennen in Apeldoorn ook op onder meer de scratch, de puntenkoers en de afvalkoers.

Trouw aan sprint
Zijn voormalige sprintmaatje Harrie Lavreysen bleef de sprint trouw en gelukkig maar,
want ook op de afgelopen wereldkampioenschappen op de piste in Saint Quentin en Yvelines (net onder Parijs) was de in Apeldoorn woonachtige Brabander - sinds Tokio meervoudig olympisch kampioen - weer wereldkampioen op de sprint en de keirin. Dat zijn precies ook de onderdelen die hij op de agenda heeft staan bij de nationale baankampioenschappen in Omnisport, de piste waar hij al ontelbaar veel trainingsrondjes aflegde op hoge snelheid. Lavreysen liet weten graag ook het NK toe te voegen aan zijn drukke najaarsprogramma omdat hij graag jonge talenten wil inspireren. En natuurlijk is de voormalig BMX’er een erkend truienverzamelaar, die graag voor twee titels gaat. Hij neemt het overigens op tegen onder meer Sam Ligtlee, die opgroeide in Eerbeek en

In de voetsporen Ook op de duuronderdelen zijn er enkele WK-gangers te aanschouwen met de Drentse Maike van der Duin voorop. Met haar medailleoogst van het afgelopen wereldkampioenschap in Frankrijk (met eremetaal op de scratch en het omnium) lijkt ze hard op weg om in de voetsporen van de zo succesvolle Kirsten Wild te treden. Wild nam na Tokio 2020 afscheid, Van der Duin richt zich op de volgende uitgave van de Olympische Spelen in Parijs 2024. Op haar route richting dat doel pikt ze ook het Nederlands baankampioenschap in Apeldoorn mee eind deze maand, waarin ze een vol programma heeft.


Noem een duuronderdeel en Van der Duin is van plan er haar snelle benen te laten zien. Ze neemt het op tegen onder anderen Mylene de Zoete en Daniek Hengeveld, rensters die volgend jaar rijden voor internationale teams als WNT-Ceratzit en Team DSM. Ook zij reden het afgelopen WK, zoals ook geldt voor de mannelijke vertegenwoordiger Philip Heijnen, onlangs nog smaakmaker van de Wooning Zesdaagse in Rotterdam.
Regionaal talent
Natuurlijk heeft de piste van Omnisport in Apeldoorn ook aantrekkingskracht op regionaal talent. Voormalig olympisch kampioene Elis Ligtlee (Eerbeek) en meervoudig wereldkampioene Kirsten Wild (Zwolle) gaven eerder al dat de aanwezigheid van een toppiste in de eigen regio
eraan bijdroeg dat ze zich vol overgave op het rijden op de baan zijn gaan richten. Op dit NK is talent van heel nabij te zien. Wat te denken van Justus Willemsen uit Apeldoorn, die met de Fries Elmar Abma deze zomer zilver won op het EK Koppelkoers en komende winter bij de elite/beloften gaat kijken hoever zijn mogelijkheden reiken. Hij komt in de duuronderdelen uit en gaat proberen zich in de strijd om de medailles te mengen. Dat doet op de sprintonderdelen Lars Romijn uit Apeldoorn eveneens.
Het Nederlands Kampioenschap Baanwielrennen biedt van 27 tot en met 29 december een compact en boeiend programma, waarin zowel de absolute wereldtop bij de mannen en vrouwen als de aanstormende jeugd en de toppers van de Paracycling actief zijn.
Wil je de sterren van de Olympische Spelen van Tokio en het WK Baan van Parijs eens van dichtbij in actie zien en bekijken hoe zij de wedstrijden naar hun hand zetten? Bestel dan kaarten via nkbaanwielrennen.nl.
Omgaan met Geld





APELDOORN - Inwoners van de gemeente Apeldoorn die meer grip willen op hun inkomsten en uitgaven, kunnen zich aanmelden voor de cursus ‘Omgaan met Geld’. Een praktische cursus met als doel weer overzicht te scheppen in de financiële situatie.
De cursus bestaat uit vier bijeenkomsten, die plaatsvinden in woonzorgcentrum Berghorst, Gijsbrechtgaarde 30 in Apeldoorn. Aan deelname zijn geen kosten verbonden. De bijeenkomsten vinden plaats op 3, 10, 17 en 24 februari. In de bijeenkomsten worden de volgende onderwerpen besproken: hoe maak je een budgetplan; hoe krijg je inzicht in je inkomsten en uitgaven; hoe kun je sparen en geld reserveren voor
onverwachte uitgaven; tips hoe je beter met geld kunt omgaan. Wie graag wil meedoen, maar niet kan in februari, hoeft niet te wanhopen. Stimenz organiseert de cursus in 2023 immers nog drie keer.

Voor meer informatie, e-mail omgaanmetgeld@stimenz.nl of telefonisch (op dinsdag, woensdag en donderdag tussen 9.00 en 12.00 uur) via nummer 088-7846464.




Wintersale bij Villa Optica!



Om ruimte te maken voor de nieuwe collectie monturen 2023 hebben we vanaf 24 december t/m 31 januari 2023 SALE bij Villa Optica!
Dat betekent dat wij KORTINGEN tot wel 75% geven op een groot deel van onze monturen collectie. Maak gebruik van deze buitenkans en kom snel kijken. Hoe eerder u bent, hoe meer keuze er is! Een deskundige oogmeting of een optometrisch onderzoek hoort daar natuurlijk bij!
Vergeet u niet uw brilvergoeding bij uw zorgverzekeraar? In veel gevallen vergoedt uw zorgverzekeraar een deel van uw bril of lenzen. Heeft u dit jaar nog recht op vergoeding? Wacht dan niet te lang. Wij helpen u graag te controleren of u nog recht heeft op een vergoeding.
50% op uw tweede paar glazen!*


Koopt u tijdens de Winter Sale twee brillen? Dan krijgt u van ons 50% extra korting op uw tweede paar brillenglazen! Zo koopt u extra voordelig een reserve bril, een bril voor naast uw lenzen, een sportbril, beeldschermbril, zonnebril of omdat u van afwisseling houdt een extra modieuze bril. Zo heeft u altijd een bril die het beste past!

www.villaoptica.nl

27
het Lavreysen zeker moeilijk wil gaan maken op het Nederlands Kampioenschap. Ook hij reed het WK dit jaar.
WINTERSALE 75% KORTING* TOT WEL
KORENSTRAAT 27 I APELDOORN I 055 - 522 00 43
*Vraag naar de voorwaarden in de winkel





















De mooiste merken in de cupmaten A t/m L 20% korting op alle MEY artikelen! MEYacti e Bij besteding vanaf € 50,aan MEY producten maak je kans op een GRATIS lingerie set van MEY! Zwolseweg 221 Apeldoorn Tel. 055-2002037 bodywearsuperstore.nl Acties alleen geldig in de winkel. Vraag in de winkel naar onze actievoorwaarden. dames enheren
Online stoelyoga om thuis laagdrempelig in beweging te blijven
APELDOORN - Bewegen.
We weten allemaal dat het goed voor je is om (verdere) fysieke belemmeringen te voorkomen. Dat geldt voor iedereen en zeker wanneer je een dagje ouder wordt. Het specifieke sport- en beweegaanbod voor senioren stijgt in Apeldoorn en krijgt meer aandacht, onder andere op de jaarlijkse Senioren Sportmarkt en -week. Eén van de beweegaanbieders met een aanbod voor senioren is de Apeldoornse Ingeborg Deichmann. Zij heeft een laagdrempelige oplossing om thuis op de stoel te werken aan het fysieke gestel.




Naar buiten om te bewegen, een blokje om of naar een (sport)locatie om gezamenlijk in beweging te komen, wordt ten zeerste aangeraden. Dit is echter niet voor iedereen mogelijk en het winterse weer kan hierin ook een belemmering zijn. Bewegen is echter wel belangrijk. “Fysieke belemmeringen zorgen er vaak voor dat er minder bewogen wordt en hierdoor wordt het risico op onder andere hart- en vaatziekte en botbreuken groter”, aldus Deichmann. Met ruim 25 jaar ervaring als yogadocent heeft ze in de coronatijd ontdekt dat online yogales voor veel mensen een uitkomst is en nog altijd aanspreekt. “Veel mensen vinden het heerlijk om vanuit eigen huis de

yogales te volgen. Ik blijf persoonlijk contact houden, dat is de meerwaarde ten opzichte van een yogales die je aanzet via bijvoorbeeld YouTube. Online stoelyoga is de oplossing voor iedereen die minder goed ter been is en liever geen yoga staand of op de grond doet. Mijn lessen zorgen onder andere voor een betere motoriek en adembeweging, meer flexibiliteit,
stabiliteit, ontspanning, betere nachtrust en minder pijn. De lessen zijn rustig en gemakkelijk op elk niveau.”
Voor meer informatie, met onder andere de mogelijkheid om een keer gratis mee te doen (of andere online yogalessen zoals mindfull slow yoga), kun je contact opnemen met Ingeborg Deichmann via info@hayoga. nl of kijk op www.hayoga.nl.

Extra stimulans voor historische publicaties over Apeldoorn

APELDOORN - De Stichting Erfgoedplatform Apeldoorn (EPA) bestaat sinds 2012 als een samenwerking van cultuurhistorische organisaties. De doelstelling van de stichting is vooral het in gezamenlijkheid organiseren van activiteiten voor de Apeldoornse samenleving.
Naast activiteiten ondersteunt het EPA ook initiatieven ten behoeve van het realiseren van publicaties en renovatie en herplaatsen van objecten die te maken hebben met het erfgoed in Apeldoorn. Zij doet dit onder andere via het Fonds Apeldoornse Historische Publicaties (FAHP). Via dit fonds wordt een bijdrage geleverd en een extra stimulans gegeven aan nieuwe historische publicaties over Apeldoorn.
Publicaties die mede tot stand zijn gekomen via het FAHP zijn bijvoorbeeld: het boek ‘Vluchteling in eigen land’. Dit boek gaat over de evacuatie van Arnhem in september 1944. Er komen ruim twintig oud-geëvacueerden aan het woord met verhalen over hun belevenissen, niet alleen tijdens de uittocht uit Arnhem en omgeving, maar ook over hun verblijf in Apeldoorn en

elders op de Veluwe. Tevens wordt aandacht besteed aan de terugkeer naar Arnhem in de periode juni tot en met augustus 1945.
Het boek ‘Doe de was de deur uit’ behandelt de geschiedenis van de vele wasserijen in Apeldoorn. Vanwege het heldere en zuivere water op de Veluwe ontstonden er in het verleden tientallen wasserijen in de gemeente Apeldoorn. En er zijn diverse boeken uit de serie Wijk in beeld, bijvoorbeeld ‘Berg en Bos, een verrassende ontdekking’ over de wijk Berg en Bos. Het fonds is in het verleden door de gemeente Apeldoorn gestart, maar was nagenoeg leeg. Het Erfgoedplatform heeft het fonds opnieuw gevoed met een eenmalige bijdrage van €10.000, alsmede jaarlijkse donaties van €5.000; tevens wordt getracht via andere
Kerstnacht in de Grote Kerk
APELDOORNZaterdagavond 24 december staan weer de traditionele kerstnachtvieringen in de Grote Kerk op het programma. Er komen veel klassieke kerstliederen voorbij, begeleid door Herman Jansen

op het orgel en met medewerking van de Brass Band Apeldoorn. Er zijn twee diensten: om 20.00 uur en 22.30 uur. Er is een mooie kerstige samenzang met diepgang. Voorganger is dominee Hester Smits.
wegen (bijvoorbeeld middels crowdfunding of schenkingen) het fonds verder te laten groeien. Daarmee kan het een stimulans bieden om meer informatie over de rijke Apeldoornse geschiedenis te publiceren.
“Wil je dit fonds steunen? Dat kan bijvoorbeeld via een schenking. Zowel het EPA als het FAHP zijn erkend als ANBI-organisatie, dus de schenking is (deels) van de belasting aftrekbaar”, aldus Ben Mouw, voorzitter van het Erfgoedplatform Apeldoorn. Voor meer gegevens, zie www.erfgoedplatformapel doorn.nl.
Kijk op Samen055.nl/centenkwesties Geen g€ld voor tampons? Vraag ons om advies! Onbetaalbaar... daarom gratis Elke week in uw brievenbus Iedere dag online! www.stedendriehoek.nl M Nieuwsblad-Stedendriehoek - N @Stedendriehoek - P Stedendriehoek VOLG ONS OOK OP SOCIAL MEDIA AL HET NIEUWS IN DE REGIO APELDOORN, DEVENTER EN ZUTPHEN 29
Aangenaam, wij zijn Pearle Studio. Die nieuwe opticien bij jou in de buurt. Op de plek waar eerst Eye Wish zat.

We zijn jouw persoonlijke oogexpert maar met een nieuwe naam. Én, met alle aandacht, geweldige service, kundig stijladvies én een premium collectie. Voor iedereen die daar oog voor heeft.






Voor wie verder kijkt
Dus wil je ook uitgebreid kiezen uit prachtige merkmonturen? Zoek je perfect passende lenzen? En wil je goed en persoonlijk geholpen worden? Dan kom je toch gewoon even binnen! Er staat altijd een collega klaar om jou beter te leren kennen. Zo vinden we samen jouw perfecte match én de beste zichtoplossing.


Kijk verder en kom verder bij Pearle Studio. Zien we je snel?
Hoofdstraat 100 Apeldoorn

BAK VAN DE WEEK
“Die teckel van u heeft in mijn kuit gebeten! Vindt u dat normaal?” roept een man woedend tegen de bazin van de hond. Ze haalt haar schouders op en zegt: “Toch wel. U kunt van zo’n klein beestje immers niet verwachten dat hij u in de neus bijt.”
De winnaar van deze week is Jessey Strong uit Apeldoorn die van de Stedendriehoek vijf euro ontvangt.
VLEUGELS
‘Ik probeer het écht,’ begint de rooie kater, baldadig maar lief. De dieren zitten in een kring, egel gooit nog een blokje hout op het vuur. Het schaap deelt plakjes hooi uit, maar echt honger hebben ze niet.
‘Dat is soms al genoeg,’ fluistert de oude kat, wijs maar ondapper.
‘Ik heb het gevoel,’ zegt de kleine pony, ‘dat ik nooit meer vrolijk kan worden. Ook niet van kadootjes of de kerstman.’
De kraaloogjes schieten allemaal zijn kant op.
‘Zelfs niet van het rendier?’ vraagt de bruine koe verwonderd.

‘Zelfs daar niet van,’ snikt de kleine pony, zijn vacht is langer
VACATURES
dan zijn beentjes. Het grote paard is er nu een aantal weken niet en de boerderijdieren vinden dat moeilijk.
In het begin werd hen vaak gevraagd hoe het met ze ging. Maar de laatste tijd niet meer.
De bosdieren zijn zelf allemaal druk met het verzamelen van spulletjes voor de winterslaap.
‘Ik kan ’s nachts niet slapen,’ zucht het schaap met een vlek op zijn rug, ‘ik ben zo bang dat ik hem ooit vergeet.’
De dieren knikken. Er glijdt een
ADVERTEREN?
BEL 055-5219878 of mail naar verkoop@stedendriehoek.nl via website https://www.stedendriehoekadverteren.nl/driehoekje
SCHILDERWERK
Schilders vragen schilderwerk. Buiten+Binnen schilderwerk.
Kwaliteit schilderwerk.
Tegen de laagste prijs. Garantie op de werkzaamheden.
Vrijblijvende prijsopgave. Kleur advies. Tel.: 06-26641752







MOTOREN
Motorliefhebber zoekt motorfiets tot 1980. BMW, Honda, etc. Ook lang stilstaande. Tel.: 06-22571321.
TUINEN
Het bestraten van tuin, terras, oprit, terrein etc. en tuinaanleg, eventueel ook levering van alle materialen. Sinds 1966. Klomp, Tel.: 06-54973731.
NIEUWJAARS VLOOIENMARKT
ZELHEM
Zondag 8 januari 09:00-16:00
Bijlesdocenten/studenten gezocht: bijles aan huis
ABACUS Bijlesinstituut tel 055-2032056 www.abacus-bijlessen.nl

MEDEDELINGEN/OPROEPEN
Man zkt wandelmaatje (v) voor mooie wandelingen in de regio. Samen genieten van de natuur en de gezelligheid. Een hond erbij is ook leuk! Email: veltman60@gmail.com of tel: 06-37198550.
STOFFEREN

STOFFEERDERIJ JOHAN
Jarenlange ervaring met het stofferen van al uw MEUBELEN, opvullen van KUSSEN en inkleuren van leer, biezen en rieten matten. BEL: 06-22926757.
SCHILDERWERK
N.T.F diensten Ervaren schilders bieden zich aan voor al u schilderwerkzaamheden. Zowel binnen als buiten . Houtrotreparatie, spuitwerk, enzovoort. Vrijblijvende prijsopgave Tel : 0616070592
traan over de wang van de kleine pony. ‘Zouden we ons ooit nog eens blij voelen?’ De ogen richten zich op mij. Bij moeilijke vragen kom ik er aan te pas, dat is vaste prik. ‘Jawel. Maar dat duurt even. Dat geeft niks. Verdrietig hoort ook bij het leven, ook al is huilen naar en stom.’
Het bonte boeltje zit stilletjes naast elkaar. ‘Misschien dat ik wel nooit meer wil lachen,’ oppert de zwarte
koe, zacht maar niet snugger. ‘Als we elke dag een moment aan hem denken. En elkaar een verhaaltje over hem vertellen, dan kunnen we hem nooit vergeten. Dan leeft hij, in onze verhalen.’
De pony slikt en kijkt op. ‘Mag je die dan ook een beetje verzinnen?’
De kring overlegt. Er wordt besloten dat je alleen verhalen mag bedenken als ze mooi en goed aflopen. Daar is iedereen het mee eens. Er verschijnt een klein glimlachje rond de mond van de kleine shetlander.
‘Dan verzin ik dat hij kon vliegen!’ De dieren kirren. Vanaf nu krijgt het grote paard vleugels. En zij daarmee ook.
Vers vlees slagerij
Cordon bleus kg. 6,99
Magere varkensrollade kg. 7,99 Carpaccio 500 gr. 8,99 Herten rosbief kg. 18,99 Hamburgers 10 stuks. 7,99 Achterham 100 gr. 1,39 Vleesribben kg. 4,75



Anita bellen Afhalen en bezorgen. Tel.: 06-29819997 of 06-20653798.

DIVERSEN




Gevraagd: oud ijzer, accu’s, metalen en witgoed. Wij komen het bij u halen. Eventueel tegen kleine vergoeding. Tel.: 06-14101933.
AB Hoenderloo
VVV-kantoor Stuijvenburchstraat 36 6961 CW Eerbeek Bospark De Schaapskooi Centrumweg 5 8162 PT Epe Bakker v/d Wal Jolink Markt 9 8161 EE Epe
VVV-kantoor Pastoor Somstraat 6 8162 AK Epe Supermarkt de Spar Vaassenseweg 12 8166 AV Emst
Benzinestation Tellegen Hoofdweg 41 8166 AC Emst
VVVkantoor Daam’s Molen Molenstraat 18 8171 CE Vaassen Albert Heijn Houtzagersstraat 6 8171 CW Vaassen Boekhandel Oonk Primera Stationsstraat 4 7391 EK Twello Gemeentehuis Voorst H.W. Iordensweg 17 7391 KA Twello DZ - DeventerZiekenhuis Nico Bolkesteinlaan 75 7416 SE Deventer Bibliotheek Centrum Deventer Stromarkt 18 7411 PK Deventer Supermarkt Plus Beestenmarkt 3 7413 ZA Deventer Dirk van den Broek Dreef 150 7414 EJ Deventer Coop Supermarkt Molenweg 1 7396 AA Terwolde Dorpshuis ‘t Trefpunt Molenweg 53 7213 XD Gorssel Bibliotheek Keijzerslanden Graaf Florisstraat 3 7415 LK Deventer Bibliotheek Colmschate Flora 259, Colmschate 7422

Deventer Jumbo Hans Kok Flora 2, Colmschate 7422
Deventer Facalitaire Zaken Gem. Deventer Grote Kerkhof 1 7411 KT Deventer Roemar koffie Walstraat 45 7411 GJ Deventer Readshop Dreiumme Dreiumme 55 7232 CN Warnsveld VVV kantoor Zutphen - TIP Houtmarkt 75 7201 KL Zutphen Stichting Sutfene Coehoornsingel 3 7201 AA Zutphen Gelre Ziekenhuis Den Elterweg 77 7207 AE Zutphen


KERST


Ieder jaar wordt een tweeduizend jaar oude verjaardag gevierd. Met wat Oudgermaanse invloeden erbij zoals een mooi versierde boom. Een nieuwigheid van deze tijd is dat de boom ook van plastic kan zijn met felle LED-lampjes erin. Wat blijft is dat het een tijd voor bezinning is waarin families, vrienden en geliefden samen komen. Dat blijft een waar wonder.
COLOFON



Postbus 638, 7300 AP Apeldoorn Kantoor, redactie en administratie: Asselsestraat 140, 7311 ET Apeldoorn. Tel. 055 - 5219878



verkoop@stedendriehoek.nl redactie@stedendriehoek.nl www.stedendriehoek.nl Klachten bezorging: 055 - 303 4901 klachten@stedendriehoek.nl Volg ons ook op:


M N S V P
Sluitingstijd advertenties: maandagmorgen 12.00 uur Redactie: vrijdag 17.00 uur voor de week van verschijning Advertentieverkoop: tijdens kantooruren 09.00-17.00 uur.

Acquisitie: Jacqueline Boekema, John Ruisch, Sacha van Beers, John Herbrink Hoofdredactie: Marc Looijen Vormgeving: André Mos, Sterre de Ronde, Jack Willemsen Administratie: Suzanne Boekema-van Buijsen Opgave rubrieksadvertenties (3-hoekjes) Apeldoorn: Kantoor Asselsestraat 140 of via: www.stedendriehoek.nl Uitgave van Uitgeverij Stedendriehoek B.V. Directie: J. Boekema, F. Boekema Oprichter: J.P.S. Boekema
Niets uit deze uitgave mag overgenomen worden, zonder toestemming van de uitgever. In verband met de eisen die recent zijn gesteld door de General Data Protection Regulation (GDPR), willen wij u wijzen op onze privacyverklaring die u kunt vinden op de site: www.stedendriehoek.nl/privacybeleidvan-uitgeverij-stedendriehoek. Bij ingezonden persberichten en foto’s wordt verwacht dat rekening is gehouden met ons privacybeleid en de foto’s rechtenvrij zijn.
WEEKENDDIENSTEN
APELDOORN
Huisartsen: Spoedgevallen telefoon 0900-6009000.
Apotheken: Gelre Lukas. Spoedrecept. ma.-vrij. 17.30-24.00 za./zo./ feestdagen 08.00-24.00. Na 24.00 uur, telefoon 0555811840.
Tandartsen: weekend telefoon 0850189466.
Dierenartsen: Bel uw eigen dierenarts Medifoon Apeldoorn: weekend 0900-55.555.555 (100 cpm)

DEVENTER
Apotheken: Apotheek Salland, 24 u. centrale hal Deventer Ziekenhuis, Nico Bolkesteinlaan 75, telefoon 0570-536505.

Huisartsen: voor spoed telefoon 0570-501777. Tandartsen: 24, 25 en 26 december, Tandartspraktijk van Houten, Van Hetenstraat 69, telefoon 0570-546916.

Dierenartsenpraktijk: Keizerslanden, Graaf Florisstr. 1b, tel. 0570-622288.
TWELLO: Dierenkliniek Twello B.V Molenstraat 49, Twello, telefoon: 0571-272624
GROOT COLMSCHATE
Huisartsen: Centraal telefoon: 0570-501777.
Regio Dierenambulance 0900-9991999 (45 eurocent).







VOORST-KLARENBEEK
Dierenartsen: De Driehoek, telefoon 055-3012255.
ZUTPHEN: Huisartsenpost Zutphen: telefoon 0900-2009000, werkdagen 17.00-08.00 uur, weekend 24 uur bereikbaar.

Apotheken: Dienstapotheek Gelre Apotheek Zutphen, Den Elterweg 77, tel. 0575-744800.
Tandartsenkring Zutphen e.o. Spoedgevallen weekend telefoon 0575-512288.

Dierenartsen: De Graafschap Dierenartsen, 24-uurs dienstverlening, telefoon 0575-587880.
WARNSVELD Homeopathie praktijk: zaterdag 10.00-12.00 uur en op afspraak via tel. 0575-573103.
Rodi Rotatiedruk werkt milieuvriendelijk en verantwoord. Waterless Printing, ISO 14001 Grafimedia en KVGO. Dit krantenproduct is geproduceerd door Rodi Rotatiedruk onder gecontroleerde omstandigheden conform ISO 14001 Grafimedia getoetst door de SCGM, Certificaatnummer SCGM-MZ:2011.01.02 31
jes Naam: ____________________________________________________________ Straat + huisnr.: ____________________________________________________ Postcode: _________________________________________________________ Plaats: ____________________________________________________________ Stuur uw oplossing voor 27 december 2022 naar Uitgeverij Stedendriehoek, Asselsestraat 140, 7311 ET APELDOORN of per e-mail naar puzzel@stedendriehoek.nl MAAK KANS OP EEN LEUKE PRIJS AFHAALPUNTEN NIEUWSBLAD STEDENDRIEHOEK Gelre Ziekenhuis Albert Schweitzerlaan 31 7334 DZ Apeldoorn Ten Teije Healthcenter Heemradenlaan 101 7329 BZ Apeldoorn Malkander Zwembad Dubbelbeek 56 7333 NJ Apeldoorn Café de Paris Raadhuisplein 5-7 7311 LJ Apeldoorn Esso Tankstation Deventerstraat 41, 7311 LV Apeldoorn Monkeytown Sleutelbloemstraat 71D 7322 AJ Apeldoorn Talma Borg Fortlaan 47 7325 ZE Apeldoorn Jumbo Eglantier De Eglantier 606 7329 DN Apeldoorn De Vischmarkt, WC ‘t Orden Laan van Orden 199 7312 KH Apeldoorn
Broodhuis Apeldoornseweg 16 7351
Lokaliteit
3 6 168 48153 4 92 18756 35 1 53261 364 1 2 74 1 574 3 62 96832 2 9 74983 825 296 4 19 CONTACTEN NIEUW: Erectiemiddelen bestellen?
LP
LL
uur Sporthal
POL, Vincent van Goghstraat 72 Inf.
hr
animo-vlooienmarkten.nl Tuinen De Roode Hoeve Middendijk 14 Nijbroek. www.tuinenderoodehoeve.nl LAATSTE 3 SFEERDAGEN Vrij. 23 + Za 24 dec. én 2e KERSTDAG 10-17 UUR VVV 25 JAAR VVV KRINGLOOP RE-SELL Voor overtollig huisraad en inboedels ‘tegen betaling’. Wij verzorgen ook het correct leegruimen, schoonmaken en opleveren van uw woning of bedrijf. Kringloop Re-Sell Coenensparkstraat 36, 7202 AN ZUTPHEN Tel.: 06-12354175 POSTZEGELS, MUNTEN, ZILVER & GOUD; GRATIS TAXEREN VOOR VERKOOP BIJ T.G. Gibsonstraat 17 - Deventer - 0570 831255 - www.hetinkoopkantoor.nl ADVERTEREN? bel voor meer informatie: tel.: 055-5219878 Hoge Hondstraat 89 • Deventer • Tel.: 06-38075414 • e-mail:versvleesslagerij@gmail.com Vers vlees slagerij Let ook op onze facebook aanbiedingen! !
DE
kraam
06-39108152
OPENINGSTIJDEN WEEK 51/KERSTWEEK DINSDAG 20 DECEMBER TOT EN MET ZATERDAG 24 DECEMBER GEOPEND
donderdag 22 t/m zaterdag 24 december
Vleesribben 3 kg. 14,50 Balkenbrij kg. 6,99 KOOPJES V/D WEEK: Kipfilet haasjes kg. 6,99 Verse braadworst kg. 5,99
Aanbiedingen voor
ZOEK DE 10 VERSCHILLEN
“Het moeilijkst? Dat ik niet meer ben wie ik was”
ook op mijn partner en kinderen komt enorm veel af. Ik heb geen werk meer, mijn conditie is erg achteruitgegaan, mijn evenwicht en concentratie zijn verminderd en ik heb epilepsie. Maar het moeilijkst vind ik het dat ik door de hersenschade snel overprikkeld ben, dingen zijn snel te veel. En de angst voor wat ons nog te wachten staat gaat iedere dag door mijn hoofd. Het enige dat we weten is dat ik zeer waarschijnlijk niet meer beter zal worden.”
“Het ziekenhuis biedt duidelijkheid, Coco houvast en een vangnet”
Begeleiding thuis
“Na de laatste chemokuur viel ik in een groot gat.” Anneke van Zoolingen (40) heeft een hersentumor. “Ik besefte: ik ben ongeneeslijk ziek. En door de hersenschade ben ik een compleet ander mens geworden. Wat nu? Op dat moment kwam Coco in beeld.”


“Twee jaar geleden kreeg ik ineens een epileptische aanval. De oorzaak bleek een hersentumor te zijn. Die diagnose was de start
van een rollercoaster aan onderzoeken en behandelingen. Ik werd geopereerd en raakte een deel van mijn gezichtsvermogen kwijt, zat midden in coronatijd zes weken lang intern in Groningen voor een protonenbestraling en onderging twaalf chemokuren.”
Zwart gat
“Na de behandelingen viel ik in een groot gat. Mijn leven staat volledig op z’n kop en
“Twee jaar lang had ik allerlei hulpverleners gehad. Maar geen van hen sloot goed aan bij mijn hulpvragen. Totdat de neuroloog mij in contact bracht met Coco. Zij werkt als oncologieverpleegkundige in Gelre, maar komt ook bij patiënten thuis. Ik had meteen een klik met haar. Coco is er voor mij én voor mijn vriend en kinderen. De strijd tegen hersentumor is een oneerlijke strijd. Toch moet je door, of je wilt of niet. Ik ben blij dat Coco daarin naast ons staat.”
Lees het ervaringsverhaal van Anneke op: www.gelreziekenhuizen.nl/patientverhalen
Een hersentumor is erg ingrijpend. Oncologisch verpleegkundige Coco Samuels begeleidt patiënten en naasten zowel in het ziekenhuis als thuis, vanaf de eerste diagnose tot en met het overlijden.
“Een primaire hersentumor is een aandoening met ingrijpende gevolgen voor patiënt
én omgeving. Zij moeten leren omgaan met de vaak sombere levensverwachting én met de neurologische beperkingen of gedragsveranderingen als gevolg van de tumor”, vertelt Coco. “De lichamelijke en psychische veranderingen hebben een grote invloed op het dagelijks leven, bijvoorbeeld op werk, alledaagse activiteiten, hypotheek, kinderen en relaties.”
Bij de zorg voor patiënten met kanker zijn vaak tientallen verschillende zorgverleners betrokken. Veel zorginstellingen werken daarom al met één vast aanspreekpunt: de casemanager. Voor de kwetsbare groep mensen met een primaire hersentumor gaan Gelre ziekenhuizen en thuiszorg Vérian nog een stap verder. Coco: “Als oncologieverpleegkundige ben ik in dienst bij het ziekenhuis én bij Vérian. Daardoor kan
ik de begeleiding die in het ziekenhuis begon, bij de patiënt thuis voortzetten. En heb ik korte lijntjes met zowel het ziekenhuis als met de huisarts, thuiszorg en andere zorgverleners en organisaties in de regio.” De zorg aan huis wordt betaald vanuit de basisverzekering. Lees het uitgebreide verhaal van Coco op: www.gelreziekenhuizen.nl/zorgverlenerverhalen
Lezing over (de impact van) primaire hersentumoren
Voor: partners en directe naasten Datum: 18 januari 2023 Plaats: stichting ‘kLEEF! in Apeldoorn
Zorg beter voor elkaar
gelre.ziekenhuizen gelrezkh gelrezkh
ADVERTORIAL GELRE ZIEKENHUIZEN
Unieke samenwerking voor mensen met een hersentumor






































































































































































































































 GEBRACHT VOOR UW GEMEENTE?
GEBRACHT VOOR UW GEMEENTE?




















































































































































































































































































































































































 Foto: Carlo Bruil
Foto: Carlo Bruil












































































































































































































































































